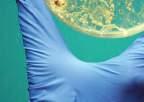

In everyday life, we rarely hear the mysterious word “fractal,” but we encounter them on a daily basis. Trees, mountains, smoke, plants, and even the circulatory system have fractal structures.
Fractals can be applied in various areas: from image compression algorithms to the study of blood vessels of living organisms. So what is a fractal?
In the language of mathematics, a fractal is a set with the property of self-similarity. In other words, each member of the set is an exact or approximate copy of a part of itself. One of the simplest examples to help us understand fractals is a Koch snowflake . Let’s build one first for ourselves:
The Koch snowflake is a geometric fractal , as are the Cantor set , the Sierpiński triangle , the Peano curve (space-filling curve), and many others. It was with these models that the theory of fractals began in the 19th century, due to the fact that the properties of self-similarity are most apparent in geometric fractals.
Cantor set
Fractals are described by simple rules, which must be performed repeatedly. The advent of the computer caused a revival of interest in the study of fractals, as they were perfectly suited to perform such operations.
● 1 Draw an equilateral triangle.
● 2 On each side of the triangle, draw more equilateral triangles.
● 3 On each side of the smaller triangles, draw even more triangles, and so on.
The Koch snowflake occupies a limited area. For example, it can be limited to a circle of a certain length. But meanwhile, the snowflake has an infinite perimeter(!). Say that the triangle’s side is one whole. Then, with each step, its length (l) increases 4/3 times. It is easy to derive the ratio of the length of the side at n th step,
Fractals are a highly abstract mathematical concept, but, surprisingly, we frequently encounter objects in nature which possess their main property — self-similarity. This is linked to two main trends in the practical application of fractal theory. Firstly, there are attempts to copy a natural fractal object using a simplified mathematical model. Computer animation achieved great results in this trend. Secondly, there are e orts to analyse a natural object and reveal the fractal structures within it.
Hindu temples have self-similar fractal structures, wherein separate parts resemble the whole. The central tower represents the deity Shiva, and the groups of similar smaller towers are the endless repetition of the universes in Hindu cosmology.
The Khajuraho Group of Monuments
Coastlines are the most unusual example of fractals. If in the rest of these examples, a person could visualise the object in its entirety, then coastlines are more complicated: standing on the ground, you can only observe a small portion of the shore.
Corals, sea stars, hedgehogs, broccoli, coastlines, mountain ranges, and snowflakes all possess fractal properties. One of the clearest examples of this structure is a tree. Many branches extend from the trunk of the tree, and from those, smaller branches, and so on.
The tree possesses the main property of fractals, self-similarity: each branch is similar to the whole tree. The human circulatory system is also arranged in a similar way. From the arteries, thinner vessels, called arterioles, extend. From arterioles, capillaries extend, which are the smallest of all vessels. Due to these properties of blood vessels, scientists have been able to study and explain various anomalies in the human body.
In the 14th century,
V developed a rule about the thickness of tree branches: “all the branches of a tree at every stage of its height when put together are equal in thickness to the trunk.” Scientists have not found an exact explanation for this phenomenon. Some associate it with the transportation of water in the bark of the tree, while others believe it is due to the tree’s resistance to external mechanical influences.
Blood vessel system of a heart
Lake Atatürk is a water reservoir created by the Atatürk Dam. It is the third-largest lake in Turkey, second in size only to the Tuz and Van reservoirs. This photo was taken by astronaut A I from the International Space Station.
Measuring the length of a shoreline is an extremely di cult task. First, it is not a straight line; the shoreline bends and curves anywhere from a few meters to a few thousand kilometres. The coast has so many bends of varying lengths that it is di cult to find and measure them all. Because of these variances, if you divide the coast into segments of 50 km and count the total length of the segments, the result will be radically di erent from what you get if you divide the coastline into 100-km segments and sum those. English mathematician L F R encountered this paradox in 1951. He noticed that Portugal thought the length of their land border with Spain was 987 km, while Spain thought it was 1,214 km. They solved this problem by adopting the smallest fragment as a unit of measurement. For example, if the length of a coastline is measured in kilometres, then small bends which are much less than 1 km long are not taken into account.
Leonardo da Vinci’s drawingA fractal algorithm for image compression has a high compression ratio: the image becomes much smaller in size, which saves memory on the computer. The compression ratio when using a fractal algorithm is roughly comparable to the most popular compression method, JPEG.
The essence of the JPEG function is the detection of “self-similar” proportions of the image. This makes it possible for the image to increase in size later while preserving its quality.
Clouds, trees, flowers, mountains, the sea, and many other natural objects that can be seen in computer games and cartoons are generated with the help of fractal algorithms. When using the fractal method, you do not need to draw each detail of a graphic object separately (a tree branch, mountaintop, or flower petal); you can simply set the initial parameters of the algorithm, and the rest of the work will be done by the computer. Because of this, it is also possible to change an object quite quickly just by altering the initial parameters of the algorithm.
Live tree
CG tree
Modern medical equipment (MRI and tomography) allow you to obtain a huge amount of digital data about the internal organs of a patient. The computer performs a mathematical analysis of this data and identifies fractal structures. Cancerous tumours and emphysema have a more complex structure, while healthy areas are simpler. The principle of self-similarity in a fractal allows us to reveal deviations in the very earliest stages and do so automatically, without the participation of a doctor.
Lung cancer
Cancerous tumours are made through the anomalous, rapid growth of cells, which are accompanied by the formation of new and disordered blood vessels. Healthy blood vessels have an ordered fractal structure.
Normal vasculature
Tumour vasculature
Modern engineers use high-tech cables, which are woven according to the fractal principle (a cable is formed from a bundle of cables, which are, in turn, formed from smaller wires, and so on).
The Golden Gate Bridge (San Francisco, USA) is one example in which such technology was used.
Strands of History, 1936–1976.
Golden Gate Bridge original suspender cable. Souvenir.
Cross section of the Golden Gate Bridge’s cableThis term is often found in science fiction because authors love to attribute the most unbelievable properties to this mysterious substance. But what does science know about it? First of all, antimatter actually exists. Secondly, there is very little of it. And thirdly, it can shed light on the laws under which our universe exists.
It all started with the idea of antigravity . In the 1880s, British physicist and mathematician W H (don’t mix him up with Peter Higgs!) was considering the vortex theory of gravity. According to this theory, the attraction between bodies arises from vortices of aether which penetrate space. Hicks proposed that a substance with negative gravity exists. Another British physicist, S A S , reduced this idea to the term “antimatter,” which he used in a letter
Consider Dirac’s simplified relativistic equation for an electron.
This equation for calculating energy has two solutions: negative and positive. But the negative value was discarded as impossible because, as energy changes continuously, it cannot change its sign. But Dirac set out to explain and interpret the physical meaning of negative energy . In quantum theory, unlike the classical theory, changes in energy occur intermittently .
Dirac suggested that the negative energy levels are already filled with some kind of invisible particles (called the Dirac sea ). Suppose that we transfer energy to one of these particles. According to our expectations, it should move to a higher energy level in the positive area, where we will see it as an electron. At the particle’s place in the negative zone, a “hole” is formed. Because there was a negative particle (an electron) here before, the hole must acquire a positive charge exactly equal to the charge of the electron. After all, before we transferred energy to an invisible particle, it had a neutral charge (otherwise, it would be visible).
Why can’t this hole be occupied by another invisible particle? Because of the Pauli exclusion principle , according
published in the journal Nature in 1898. He also conjectured that when matter and antimatter meet, their equivalent quantities should disappear, turn into nothing, and annihilate one another (from the Latin nihil, for “nothing”). The idea was not entirely correct. It should be noted that, at that time, the scientific community had not yet fully adopted the concept of atoms and molecules. Although, in 1897, yet another British physicist, J.J. T, discovered the electron. Fast-forwarding, we can now say that antimatter does not possess antigravity, but it does know how to annihilate.
Physicists decidedly liked these terms, so they coined them as a way to describe these hypothetical phenomena. The beginning of the 20th century was a time of rapid development in physics: quantum mechanics, wave-particle duality, and other daunting ideas came into the world.
As a result of the annihilation of an electron and a positron, gamma quanta photons are formed. In the most common case, this is two photons, each of which possesses energy equal to the resting energy of an electron or positron (0.511 MeV)
to which there cannot be more than one electron in one quantum state at the same time. That is, each hole has one electron . Furthermore, Dirac suggested that, most likely, this is not just a fragment of emptiness, but a positive electron, or a positron . The Dirac model explains why the particles appear in pairs (particle-antiparticle), and energy is released when they are annihilated.
This theory was met with scepticism. It could only be proven through experimentation. They had to either find this particle or disprove the hypothesis.
Absorption of energy and transition to a high energy level
release and transition to a low energy level
When solving the Schrödinger wave equation in 1928, one of the greatest physicists in history, Englishman PAUL DIRAC, predicted that an electron should have a counterpart similar in mass but opposite in charge.
The discovery of antimatter did not take place entirely on Earth. In 1932, a young American physicist, C A , set up a series of experiments on the study of cosmic rays in a cloud chamber
Based on the deviation of the particle trajectory in the chamber, it was clear that this particle was the carrier of a single positive charge. At first, everyone thought about the good old proton. But the proton has a much larger ionisation potential (the ratio of the energy needed to detach the particle from its charge); that is, a much larger mass. This value, by magnitude, coincided with the value of an electron. From all appearances, the mass of the unusual particle was approximately equal to that of an electron.
But there was still the possibility that these were not positively charged particles but only electrons that changed direction as a result of scattering. To rule out this possibility and trace the direction of the particle’s motion, Anderson developed an elegant experiment: he placed a 6-mm lead plate parallel to the Earth in a chamber. Now the particle, passing through it, should have reduced its energy and
changed accordingly with the curvature of the trajectory. There was nothing left to do but to recognise that “positively-charged electrons” originate in space. The scientist called this particle a “positron” (from “positive electron”) and proposed changing the name of the electron to “negatron,” by analogy with the positron. Anderson’s article was published on March 15, 1933, in the journal Physical Review. However,
Trace of the trajectory of a positron in the Wilson cloud chamber from Anderson’s 1932 experiment. The particle loses a part of its energy when passing through the lead plate and rotates in the magnetic field.
The Wilson cloud chamber is one of the first instruments in history designed to record the tracks of charged particles. It was named after its inventor, Scottish physicist C W . In the chamber, a supersaturated vapour is created, through which a stream of charged particles is passed. The particles leave ions behind them, which causes the vapour to condense. The user then photographs the condensate formed along the trajectory of the particle.
Alcohol vapour condense to form liquid droplets around the ionised molecule
Lamp
Camera
Plastic lid
Felt ring soaked in alcohol (to supply alcohol vapour to the chamber)
Radioactive source (produces radiation and causes ionisation of vapour)
Dry ice (cools the alcohol vapour until it is staturated)
Foam (supports dry ice)
Cosmic rays are a stream of elementary particles and nuclei of atoms moving with high energies in outer space. They were discovered by the A ustrian physicist V H , who launched his measurement instruments in a balloon and observed that at altitude, the ionisation level of the air is higher and remains the same day and night. The baton was then passed to the american scientist R A . M, who, following the advice of the soviet physicist D S , adapted Wilson’s camera to study the tracks of cosmic ray particles. His student, C A , conducted research with a cloud chamber on mountain peaks and in hot air balloons.
A picture of the tracks of subatomic particles in a cloud chamber
six months earlier, the physicist had announced the first antiparticle in a short message in Science magazine.
And that’s how antiparticles were discovered. Well, more precisely, how one of them was discovered. In 1955, E G S and O C discovered the antiproton, winning a Nobel Prize for their work along the way. A year later, B C and his colleagues discovered the antineutron , and it thus became possible to study antimatter.
In principle, the antiproton was already the core of antihydrogen, but something was missing. In 1965, an antideuteron—a hybrid of an antiproton and an antineutron—was obtained. In the 1970s, antitritium and antihelium nuclei were discovered in Serpukhov, USSR (present-day Russia). Only in 1995 were CERN physicists able to “assemble” an antihydrogen atom. But at that time, they were separate atoms.
A real breakthrough in the study of antimatter was achieved in the 2010s. Thirty-thousand antiprotons, cooled down to –73°C, and 2 million positrons, chilled to –233°С, yielded 38 antihydrogen atoms that lived for 172 milliseconds. A year later, 309 atoms were created, and they existed for 1000 seconds!
Physicists were able to make use of much smaller quantities of antimatter. Now we know for sure that antimatter interacts gravitationally in the same way as matter. The spectrum of anti-atoms is identical to that of ordinary atoms. Therefore, we do not distinguish between anti- and normal matter through a telescope.
But the main mystery still remains: why does the world around us most likely consist of matter, while there is very, very little antimatter?
That is how much the production of a milligram of positrons, the simplest variety of antimatter, costs. This makes antimatter the most expensive substance on Earth, and it is also extremely di cult to maintain.
In accelerator experiments, particles are produced only in pairs: an antiparticle and a particle. The same thing probably happened at the time of the Big Bang — an equal number of particles and antiparticles appeared. But in that case, all matter would have been annihilated and the universe would consist of radiation alone. The paradox of the so-called Baryon asymmetry (cases in which there is matter but no antimatter) remains unresolved.
One of the most prominent versions of the paradox is the violation of CP symmetry . What is this? For a long time, it was believed that if all particles were simultaneously replaced by antiparticles and a mirror image of the physical system was made, then the laws of physics would not “notice” the inversion; everything would remain the same. This is CP invariance. What emerged from it is that there is no di erence between particles and antiparticles, including the way they come into existence.
However, in the 1960s, two American physicists proved that invariance is violated in some
instances. J C and V F won the Nobel Prize for demonstrating that invariance is violated during the disintegration of neutral kaon . Their experiments exhibited that this violation is not su cient to obtain the required amount of a substance, because reactions going backwards in time are not identical to those going forward.
It has also been suspected that dark matter consists of antimatter. But, in that case, gamma-telescopes should register signals from its annihilation. The results of a 413-week observation session of the Fermi Gamma-ray Space Telescope were recently published, but there was nothing suspicious!
On a daily basis, the same telescope observes the birth of large amounts of antimatter on Earth.
In 2011, Fermi recorded gamma-flares caused by the annihilation of positrons produced in the air by ordinary lightning. Powerful lightning, as it turned out, can produce up to 100 trillion positrons.
But most interestingly, antimatter has been at humankind’s service for four decades. During certain medical research on the human body, annihilation takes place.
One example of this stems from our need to see the activity of brain regions in real-time. What is required to accomplish this?
One cyclotron, one chemical laboratory, and a positron emission tomography, or PET scanner , the first versions of which were created back in the 1970s.
Our brain, although it only weighs 1.5–2% of our total body weight, is voracious and consumes 20% of all of our energy, generally in the form of glucose. In locations where the brain is more active at a given moment, there is more glucose in the blood. But how can we see it? It’s simple. In a cyclotron, you develop an isotope of fluorine ¹⁸F, the half-life of which is 109.8 minutes. This isotope exhibits beta plus decay, which emits a positron. Next, a typical glucose molecule is taken and one of the hydroxyl groups in it is replaced by a fluorine atom, which is close in size.
This makes 18-fluorodeoxyglucose, and you drink this solution before undergoing the test. Glucose enters the brain and the fluorine atoms continue to disintegrate.
In D B’ novel Angels and Demons , villains steal a gram of antimatter from CERN and threaten to blow up Rome. Now we know that when a substance meets antimatter, both masses disappear, turning into radiation strictly according to Einstein’s formula: E = mc 2 . As you can see, there is a monstrous magnitude in this formula — 300,000,000 mps, which is equal to the speed of light. This makes antimatter much more powerful than a thermonuclear bomb. Calculations show that the annihilation of that stolen gram of antimatter would have been equivalent to 430 kt of TNT! gram
The rest is a matter of technique. Construct straight lines in the opposite direction and, where they converge, you will “see” the point of annihilation. Where there are more annihilations, there were more fluorine atoms, and, hence, glucose. This means that it was those spots where the brain was more active. For greater accuracy, linking activity to anatomical details, you can simultaneously conduct an MRI or CT scan.
That is to say, positrons are being born right inside our brains. They don’t get very far, though: after moving just a few millimetres, annihilation occurs. The positron disappears, and two gamma quanta shoot out in opposite directions, before being “caught” by the sensors in the ring of the scanner.
Oncologists look for metastases in the same way, but instead of fluorinated glucose, they use radiopharmaceuticals that locate cancerous tumours with great precision. So antimatter is, of course, still the stu of fantasy, but at the same time, it is a reality that saves many lives every year.
Every day, more than three kilogrammes of these substances are produced per inhabitant of the Earth. No, we’re not talking about food products. We mean compounds that reduce the surface tension of liquids.
Soap can arguably be considered the most popular surfactant . Sodium or potassium salts of fatty acids make up the core of the cleansing agent, and they have a complex structure. The molecule of such acids is “bilateral”: one half repels water (hydrophobic ), and the other is attracted to it (hydrophilic ). When you soap up your hands, the hydrophobic parts of the molecules come into operation, moistening the grease. When we put our hands in water, the hydrophilic side comes into play — it attaches itself to the water and carries away the whole molecule, along with harmful substances and bacteria, into the sewer system. If you simply rinse your hands with water, the fatty particles and the contaminants they have accumulated will remain on your skin.
The polarized surfactant head
The non-polarized surfactant tail
The hydrophobic part of the molecule is active in all non-polar solvents, such as gasoline or oil, so soap is well-suited for the removal of such contaminants. It is interesting that surfactants can work only at the interface between two states: liquid-gas, liquid-solid, or two immiscible liquids. They look for boundaries between states, just like spies, and this is why substances that reduce surface tension are called surfactants , or “surface-active agents.” The surfactants have mastered an entire procedure for transit from the liquid solution to the state interface — adsorption, the essence of which lies in the accumulation of substances in the surface layer. Surfactant molecules are able to independently move to the interface of two substances.
If there are too many surfactants, more than the boundary can hold, the molecules gather into microscopic spherical
Diffusion
Micelle
Adsorption
Interconversion
Diffusion
Monomers
droplets of micelles (from the Latin “micella,” meaning a small particle).
Soap dissolves in water Surfactant ions orientate themselves in grease and water Process continues Cleaning complete Agitation begins to separate grease from surfaceThe micelle is a sphere of molecules with protruding hydrophilic ends and a diameter of a few nanometres.
Ninety-nine per cent of all surfactants are organic substances — alcohols, fatty acids, and their salts, as well as other compounds based on carbon and hydrogen. According to the stories of the ancient Roman writer P E , people were able to use such compounds as surfactants even before the common era. To do so, they mixed wood ash from beech with goat fat, and voila! The first soap was created. Later, alchemists thought up the idea of treating natural oils with sulphuric acid, and the French scientist E F prepared detergents from olive and almond oils in 1831.
In Germany in 1843, people added coconut oil to their cooking pots for soap. At first, though, the aromatic soap did not sell very well. The new product did not have the familiar unpleasant smell of rancid fat, which people had grown used to, so they thought the coconut soap to be low-quality.
Acquiring a micellar solution is simple: to make it, pour a thin stream of liquid soap into water until it becomes cloudy. Such a solution with microparticles of liquid soap, capable of wetting many surfaces, is called a colloidal solution. By the way, milk and blood also belong to the category of colloidal solutions.
White powder
Sodium lauryl sulphate (also known as sodium dodecyl sulphate or SLS) is a surfactant present in many cleaning products such as toothpaste, shampoo, shaving foam, and bath foam.
Take a thin copper wire, wrap it a few times into a spiral, and lightly grease it with vegetable oil. Gently place it on the surface of the water. Due to the low weight and hydrophobic fat, the copper wire does not sink. Now for the main act — drip liquid soap from a pipette into the centre of the spiral. The copper wire will start spinning and then sink! Soap, merely by means of its presence, enables water to moisten the fat, and the di erence in surface tension on di erent parts of the wire makes it rotate, and eventually the wire sinks. The stronger the surfactant, the faster the rotation
Sodium lauryl sulphate is a surfactant, the molecule of which contains both a water-soluble and water-insoluble part. It attaches to grease or dirt and tends to dissolve in water. This substance also reduces the surface tension of water and forms bubbles.
Modern surfactants are divided into ionic and non-ionic. They are distinguished by their behaviour in aqueous solutions; ionic surfactants become ions when dissolved. Both positive charge ions (cations) and negative charge (anions) can display surface activity. They are called cationic and anionic, respectively. Cationic surfactants are organic bases with salts, while anionic ones are organic acids with salts.
SLS is added to the paste as a foaming agent. It also irritates the taste buds in the mouth. This substance suppresses taste buds and destroys phospholipids, which act as inhibitors of acute stimuli receptors. Drinking orange juice after brushing your teeth will seem unpleasant to you since SLS dulls your taste buds and strengthens the juice’s bitter aftertaste.
Sodium lauryl sulphate is present in some engine degreasing agents. The substance is present in such degreasers in a much larger amount than in shampoos, for example. They are also used by various industries as a leather softener, wool cleanser, and floor cleaner.
Studies conducted in 2001 showed that sodium lauryl sulphate exhibits shark-repellant properties due to its hydrophobic nature. However, despite this potential application, the substance is not used as a primary means of protection against shark attacks. Semiochemicals, as well as defensive toxins of marine organisms, were proposed as alternative repellent agents.
Amphoteric surfactants are the sort of “Dr Jekkyl and Mr Hyde” among ionic substances because they are able to manifest both as cationic in acidic solutions and as anionic substances in alkaline solutions. Non-ionic substances do not decompose into ions in water, but they dissolve perfectly due to the formation of a hydrogen bond between the H20 molecule and the functional group of surfactants. Such surfactants appeared relatively recently, in Germany in the 1930s, but they already hold a steady position in the world in terms of production volume, second only to anionic surfactants.
Detergents such as soaps, washing powders, and shampoos account for almost half of the global production of surfactants. Workers in the oil industry add surfactants to water-oil emulsions to quickly get rid of impurities in the water, as well as to improve oil recovery from underground reservoirs.
We also need surfactants to mix liquids that do not want to be in the same solution, for example, oil lubricating mixtures. Surfactants are used to produce nano-objects in the process of liquid dispersion (grinding of solid bodies) and emulsification (mixing of two or more liquids that are normally immiscible).
In metalworking processes, surfactants are used as cutting fluids that reduce friction and simplify cutting and milling.
Toothy, dark blue, 1.5 m in length, covered in scales, and even with legs. Have you guessed who this is? None other than our shared great-grandmother! Of course, coelacanths, or the genus are not our direct ancestors, but they are still relatives of beings that first left the seas 385 million years ago and became four-legged terrestrial animals, from which we sprung. And these relatives are still alive today!
On December 22, 1938, floating o the South African coast in the Indian Ocean, fishermen from the Irvin & Jones Company caught an unknown creature. It weighed 57.5 kg, was about 1.5 m in length, dark blue in colour, and unabashedly chomped
its jaws. This was not just any fish — it had scales, fins, and… limbs. Or, more precisely, rudiments thereof. Moreover, there were seven of them: two on the back, three on the belly, and another pair on the head.
It should be noted that the local population occasionally caught these creatures and had even come up with a name for them, gombessa , which can be translated as “bitter fish.” The residents knew that it was nearly inedible (it was consumed due to the belief that its meat helped to cope with malaria symptoms), although it was possible to make something like sandpaper from their extremely strong and bristly scales. So for fishermen, perhaps, it was not such a curiosity; nevertheless, they called the curator of the local East London Museum, M
The museum had a standing arrangement with the fishermen, requesting that they report all unusual findings.
Ms Courtenay-Latimer and the fish she discovered
Ms Courtenay-Latimer was an ordinary museum worker, but after a single glance at the creature, she immediately realised that there was something unique in front of her. The animal was like a bridge between a fish and a lizard. She looked through the records and could not find anything similar. Meanwhile, she needed to work quickly — the fish was decomposing in the African heat right in front of her.
Ms Courtenay-Latimer had a hard time persuading a local taxi driver to take the decaying carcass to the museum or to even let her drag it into the car. And then, she had to listen to D B B , the Chairman of the museum, mocking her: “To you, all ugly ducklings seem to be swans.”
Nevertheless, she sent the fish to a taxidermist, sketched an approximate picture of the find, and sent for her friend, ichthyologist J. L. B. S , who was in a di erent city at the time.
Smith, who later wrote a book about the fish they discovered, called Old Fourlegs: The Story of the Coelacanth, described his feelings upon reading the letter
from Ms Courtenay-Latimer: ‘’And then a bomb seemed to burst in my brain, and beyond that sketch and the paper of the letter, I was looking at a series of fishy creatures that flashed up as on a screen, fishes no longer here, fishes that lived in dim past ages gone, and of which only fragmentary remains in rocks are known. I told myself sternly not to be a fool, but there was something about the sketch that seized on my imagination and told me that this was something far beyond the usual run of fishes in our seas…”
But that “burst” happened not only in Smith’s brain. At that time, the entire scientific world sat with bated breath. It turned out that the scientists had something more extraordinary on their hands than a dinosaur — it was a living ancestor, believed to have died out about 70 million years ago. In honour of Marjorie Courtenay-Latimer, Smith named the fish Latimeria
Previously, species of Latimeria were called brushfishes, but this term has since become obsolete. A specimen discovered in South Africa was named Latimeria chalumnae , and in 1997-1999, a second species (which was brown in colour), Latimeria menadoensis , was discovered and described near the island of Sulawesi in Indonesia. All other species of Coelacanthiformes are now thought to be extinct.
This fish is, of course, not our direct ancestor. Terrestrial vertebrates (also called tetrapods), to which we belong, are closer to the lungfish, an ancient group of fish possessing both lungs and gills. Nevertheless, both the coelacanth and the lungfish come from the same ancestor, and both belong to the same class of lobe-finned fish. Therefore, the “zoological sensation of the
20th century” (as Latimeria was christened) can be considered our distant relative.
Since the birth of the lobe-finned fish 400 million years ago, it has changed, albeit not too dramatically: its size has increased, its swim bladder is filled not with air but with fat, and the proportions of its body have been modified. Nonetheless, Latimeria resembles our distant forefathers. It does
not have a spine but instead something like a chord, a flexible elastic rod running along its back, which was the predecessor of our bodies. Also, it has a small appendage at the end of its body, similar to the embryo of the tails seen in amphibians. But most importantly, the coelacanth has the rudiments of limbs, the very ones that helped our ancestors to climb out from the sea onto dry land.
Sarcopterygii, or lobe-finned fish, are a class of bonefish, the first category of which is the order of Coelacanthiformes. The second, Rhipidistia, is of lungfish. Most lobefinned fish possess well-developed, fleshy blades in their paired fins.
In addition to the class of lobe-finned fish, there is the famous Tiktaalik , a more “advanced” species than Latimeria , which lived 375 million years ago and was a transitional form between fish and amphibians. It, too, was probably not our direct ancestor. Around 385–375 million
The coelacanth is a tropical fish, but that does not mean that it loves sunlight and heat. On the contrary, this fish prefers depth (from 200 to 700 m) and surfaces to the level of 80–100 m only at night.
Coelacanths are predators (again, look at those teeth!). Their diet includes fish and even small sharks. Most of the coelacanth’s meals live in underwater crevices and caves, where the fish prefers to swim. The animal’s mouth structure allows it to move not only the lower jaw but also the upper one, enabling it to e ciently suck-in food.
The coelacanth can turn upside down and hang in this position for up to two minutes. Scientists have found that, in this way, the fish detects weak electric
years ago, many “fleshy-footed” beings began to find themselves on land, just like Tiktaalik . There were many reasons for this: from the large number of arthropods who floated along the banks of rivers and lakes, to the increasing threat of predators, to the eutrophication of small
bodies of water — in those distant times, there were not enough decomposers, like fungi and bacteria, to process dead vegetation and animals, meaning that they died in the water and stayed there for a very long time, making the space very cramped.
fields, caused by contact between living tissues and water at the bottom of the ocean. To do so, Old Fourlegs has special organs called electro-receptors. Interestingly, the fin movement of the Latimeria is similar to that of the extremities of most terrestrial vertebrates: first, the fish simultaneously moves the left thoracic and right ventral fins, and then the right thoracic and left abdominal simultaneously as well.
Coelacanths have very long lifespans. They can live to see their 80th and even 100th birthday. They are also ovoviviparous, which means that they do not spawn like most fish that we know, and they do not lay eggs like lizards. Instead, they carry the eggs inside themselves. Thirteen months after conception (yes, Latimeria pregnancies last even longer than in humans), the young hatch from their eggs.
To this day, we do not fully understand how and why it arises or how to treat it. We can only relieve its symptoms — and even for a relatively long time. It spares no one: Mohammed Ali was not the only famous patient with this diagnosis. Pope John Paul II died from complications of Parkinson’s disease. The 41st President of the United States of America, George Bush Sr., su ered from this ailment; and the star of the Back to the Future trilogy, Michael J. Fox, has struggled with this disease since 1991. And successfully at that: recently, he was able to perform on stage with a guitar!
Matthew retired not too long ago. Several years ago, he discovered that it became di cult for him to move his hand, and a neurologist came to a tragic conclusion: “You have Parkinson’s disease in its initial stages. But don’t be upset — we will treat it.” From that time on, Matthew read constantly to learn more about his illness. Since he was interested in history, the first thing he discovered was the person after whom the disease was named.
J P was born on April 11, 1755, in East London to the family of surgeon John Parkinson. He followed in his father’s footsteps, becoming a doctor. He was a talented practitioner, saved many people’s lives, and even became one of the fi rst members of the Royal Humane Society (a charitable organisation which provided first aid to those who were a ected by disasters).
Parkinson was observant and noticed many things. This helped him in his scientific research: in 1817, Whittingham and Rowland published his work, “ An Essay on the Shaking Palsy ,” in which he summarised six clinical cases.
A tremor, or shaking, usually begins in a limb, often your hand or fingers. You may a rub your thumb and forefinger back-and-forth, known as a pill-rolling tremor. Your hand may tremor when it's at rest.
of few
images of
(in the centre). All of the rest, including photos found on the internet, are falsified. In Parkinson’s day, cameras had not yet been invented.
Interestingly, the a icted were not his patients — as a doctor, Parkinson often walked in the streets of London and observed people with similar symptoms.
It used to be very easy to distinguish this type of patient. First, their posture was hunched, as if they were begging. Secondly, the person’s face was practically devoid of facial expression and almost did not show emotions at all.
Thirdly, their hands trembled, hence the title of the essay “On the Shaking Palsy.” Fourthly, one of the a icted per son’s hands was extended forward as if they were counting or rotating something, like money, pills, or prayer beads. Due to muscle spasms, these people moved very little and took small steps, but sometimes, they could set o into a full run — this is called a propulsive gait. It is rare
You may speak softly, quickly, slur or hesitate before talking. Your speech may be more of a monotone rather than with the usual inflections.
Over time, Parkinson's disease may slow your movement, making simple tasks difficult and time-consuming. Your steps may become shorter when you walk.
to see such a vivid picture of the illness now, because patients generally receive maintenance therapy that alleviates many of the symptoms.
Alas, Parkinson’s contemporaries did not take note of his work: neurological diseases were not held in great esteem at the beginning of the 19th century. This illness was discovered once more by the “Napoleon of Neuroses,” J-M C, who, it seems, had a hand in studying or naming almost all neurological illnesses. Exactly 60 years later, in 1877, he described the “trembling palsy” anew and proposed renaming it Parkinson’s disease (“la mal adie de Parkinson ”).
Matthew did not stop his search, and he spent long winter evenings leafing through books. From a textbook on neurology, he learned that in his illness, clots of foreign matter formed within nerve cells, preventing them from working normally (why this happens is still a mystery). These are called Lewy bodies . “Interesting,” thought Mat thew, as he opened up a search engine in his browser. It turned out that in 1912, these strange interneuronal bodies were discovered by a German scholar, F H L. Today, we know that these bodies are made up of components of the alpha-synuclein protein and other
proteins, and they are a characteristic sign of dementia , the loss of mental abilities.
At this point, Matthew deduced that the symptoms of his illness were caused by the death of nerve cells in the substantia nigra. This idea was first proposed by Soviet neuropathologist K T.
Substantia nigra, or “black substance” in Latin, is a part of the human midbrain. This is where neurons responsible for the synthesis of the neurotransmitter dopamine are found. If they die, this destroys the neural path through which excitation is passed along to the basal ganglia, as well as the substantia nigra, which is part of the extrapyramidal system . This system controls movements parallel to
Dopamine is is an activating neurotransmitter: when it acts on another neuron, the latter’s activity level increases
Dopamine is a neurotransmitter that is produced in the human body by special dopaminergic neurons. It transmits information from one cell to another using intercellular contacts, or synapses.
When a person has Parkinson’s disease, there is not enough dopamine in their synapses, and the cell’s synthesis processes are disrupted
Dopaminergic neurons of the substantia nigra use dopamine to transmit signals to the basal ganglia, which controls the movements of an organism, making it active. When these neurons are destroyed (due to the accumulation of Lewy bodies), dopamine becomes short in supply and movement is constrained. Motor activity decreases, and muscle spasms appear.
In a brain with Parkinson’s dis ease, this is where neurons are destroyed.
the main motor system (the pyramidal, or cor ticospinal tract), maintaining muscle tone and coordinating movements. In the case of such a breach, this system is “disinhibited”: redundant movements like tremors and other characteristic symptoms appear.
Matthew realised what was happening in his brain. But what did the doctor prescribe him? And how does this medicine help?
Lack of the neurotransmitter dopa mine plays the primary role in the pathogenesis of Parkinson’s disease. Its biochemical precursor is the amino acid tyrosine. The tyrosine enzyme, hydroxylase, uses a “hanging” hydroxyl group (-OH) to convert tyrosine to levodopa (L-DOPA). In turn, the L-DO PA-decarboxylase enzyme converts levodopa into dopamine.
Dopamine is not able to pass by itself through the bloodbrain barrier — a powerful line of defence and control that prevents all of the things that “float” in our blood from entering into our brains. Therefore, taking it as a medicine is pointless. On the other hand, levodopa passes through perfectly. This promised a bright future in pharmacology.
Levodopa is an abbreviation of L-3,4-dihydroxyphenylalanine, or L-dopa. Matthew learned from a chemistry textbook that levodopa was first synthesised by the Polish chemist K F in 1911 (he also invented the word “vitamin”). This event went unnoticed for a long time, but everything changed dramatically in 1938 when German pharmacologist and physiologist P H and his collaborators discovered the L-DOPA-decarboxylase enzyme. This allowed us to understand the way that dopamine and other mediators are produced, and put levodopa and dopamine in the group of the most important “informational” molecules of the brain.
Levodopa’s fate stirred up curiosity in Matthew and he found out that in the middle of the 20th century, Swedish pharmacologist and future Nobel laureate, A K , set up an experiment: he immobilised guinea pigs with the strongest possible tranquilliser, reserpine, a vegetable poison, and then introduced levodopa to them. They went from lying on the floor with lowered ears to jumping on their feet in practically an instant!
In the early 1960s, Austrian pharmacologist D O H discovered a sharp decrease in dopamine in the basal ganglia of patients su ering from Parkinson’s disease. The facts lined up quite logically: dopamine is necessary to maintain the motor activity of the body, and levodopa is its direct biological precursor.
Matthew enthusiastically read about how Hornykiewicz consulted his colleague, Viennese neurologist W B , o ering him two grams of levodopa for clinical experiments. Intravenous administration of the substance led to a quick, albeit temporary, improvement in the condition of patients su ering from Parkinson’s disease. These first experiments allowed for a new era in the history of the illness, making levodopa therapy the gold standard of treatment.
In addition to levodopa, which in combination with carbidopa is still the only e ective drug to treat the disease, there is another method—deep brain stimulation , or DBS . It helps, but as of now, we’re not sure exactly why.
During DBS, long and thin electrodes with a width of a millimetre are implanted in the brain, pointing towards a target area the size of a corn kernel—the subthalamic nucleus in the basal ganglia. Electrodes gently stimulate it, which eases the motor symptoms of Parkinson’s disease.
After perusing the internet, Matthew learned that about 10,000 people undergo DBS operations each year for the treatment of Parkinson’s. Statistics have already aggregated the results of over 140,000 patients who have used these electrodes. The first DBS operation was performed in 1987 in the French city of Grenoble, and the patient is still alive to this day. It’s not surprising that doctors think of this method as something between science, art, and shamanism. But it prolongs life.
Matthew was most struck by a piece of information that he stumbled upon by chance: it turns out that if a section of neurons has died, new neurons can be transplanted onto the location! Experiments using this method on macaques have been very successful.
Over the past ten years, cellular technology has made a huge leap, and we no longer need the neurons of donors—we know how to grow our own. This became possible thanks to the work of Japanese scientist S Y , who developed a method for generating stem cells from existing cells in the body, such as skin (which gives rise to all cells in the body). As a result, we now can grow anything from them. Unsurprisingly, Yamanaka was the recipient of the Nobel Prize for Physiology and Medicine in 2012.
A breakthrough in the treatment of Parkinson’s also happened in Japan.
Taking dopamine as medicine is pointless. It does not pass through the blood-brain barrier, unlike levodopa.
This method is used to relieve the symptoms of Parkinson’s disease. A small neurostimulator is implanted under the collarbone. The device uses electrodes to send electrical signals to the subthalamic nucleus in the brain, blocking signals with symptoms of the illness. The method does not heal it completely, but it slows down the development of the disease, relieves symptoms, and improves the patient’s quality of life.
At the end of 2017, a clinical study for a new form of therapy began to recruit participants. Two-year long trials on macaques were successful, so all that was left was to try it on humans. Using the method proposed by Yamanaka, scientists reprogrammed the cells of healthy humans and produced young dopaminergic neurons, which were then implanted onto the brains of macaques with damaged substantia nigras. Transplantation of the neurons significantly relieved symptoms of the illness, and the observed e ects were long-term: the improvement (without tumour development) lasted for 21 months until the experiment concluded.
Today the whole world, Matthew included, waits anxiously for the results of the experimentation on humans. Parkinson’s patients have new hope. And in the meantime, Matthew decided to sign up for a consultation with a neurosurgeon to learn further about deep brain stimulation and see if this method is suitable for him. After all, he wants to stay active for as long as possible.
The idea is to replace dead neurons. After transplantation, young neurons form connections with existing cells and produce dopamine. Scientists can reprogram mature cells — for example, skin cells, into immature stem cells, from which cells of other types can be developed. Stem cells are primitive, divide actively, and are able to develop into more specialised tissues (like neurons) through a process known as di erentiation. At first, they are multiplied in laboratory conditions, and then, by acting on various growth factors, they are converted into young dopaminergic neurons. Then, they are implanted onto the brain to replace those that are deceased.
Thus, stem cell therapy may prove to be a promising strategy for the treatment of Parkinson’s. The main task at hand is to make sure that the cells do not become tumorous, and that they function normally after transplantation.
Dreamers’ visions of a forgotten world may become a reality. Only, this world is not lost in the vast expanses of South America but on the coldest continent: Antarctica. Deep beneath the ice, a giant lake is hidden, which was isolated from the outside world for millions of years. What awaits us at its bottom?
Antarctica was lucky: in 1959 in Washington, the 12 countries that had scientifi c missions on the continent signed an agreement to ban establishing military bases, conducting military manoeuvres, and testing any kind of weapons on its territory. Since then, humans have gone there exclusively in the name of science. The results of the work of one such mission suggested that at a depth of several kilometres under the ice cap of Antarctica, the temperature is close to the melting point of ice. This assumption was expressed in 1957 and was the first step to a grand discovery. Another mission involved seismic soundings of ice in the area of the Soviet-operated Vostok Station (The word vostok means “east” in Russian), which was conducted by a scientifi c expedition led by Soviet geographer A K , son of Nobel laureate P K . As a result, a signal was recorded, refl ecting off a surface under the ice. For about 30 years, it served as evidence of the presence of a layer of frozen rock under an ice shell many kilometres deep. However, the reflecting plane was so smooth that even Andrey
Kapitsa suggested that there must be a huge subglacial lake with a length of more than 250 km, a width of 50 km, and a depth of more than 1 km!
It wasn’t until the 1990s that a technique was developed to confirm the existence of a body of water. The powerful radar and modern radio-locating method of geomagnetic deep sounding (GDS) enabled a British-Russian collective of scientists, led by G R , to get results that even the most consummate of sceptics could not doubt: there is a giant lake under the layers of ice. Its contours appear on the icy surface of the continent. Jeff Ridley proved this in 1993 through the use of extremely precise satellite laser altimetry. It turns out that the Vostok Polar Station is in the centre of an icy plain that is as flat as a table and can be considered a projection of the lake onto the surface.
The water in the lake has been completely isolated from the outside world for several million years. However, evolution continued there, and biological species appeared and went extinct. Life underwater “froze,” which, of course, means it is of great interest to researchers.
In 1990, the first thermal drills dug into the ice of Antarctica in the area of the Vostok station. The goal was to get to the lake and take samples of its unique water. It should be noted that Soviet scientific expeditions had been drilling into the ice of the southern continent since the 1970s — four of their wells were classified as being deep. Therefore, when the thermal borehole at Lake Vostok was drilled, the well was called “5G”, from the Russian piataia glubokaia , or “fi fth deep well.” This was achieved through thermal boring, when ice is melted by the movement of a heated drill head. This required a huge amount of electricity— ten times more than with traditional mechanical drilling. For this reason, and also because of the poor quality of the ice patch selected, the researchers switched out the thermal drill for the electromechanical KEMS-132. This shift happened at a depth of 2,755 m.
The lake was named Vostok in honour of the Soviet scientific station established in this district in 1957
The climatic conditions at the Russian Vostok station are probably the most severe on the planet. In July 1983, the lowest temperature on Earth was recorded there: –89.2 °C (in such cold, eyeballs freeze almost instantaneously). The altitude of the station, 3,488 m above sea level, causes a constant
shortage of oxygen among polar explorers. The multi-month adaptation required in these conditions is very taxing for the body: weight loss can reach 10–12 kg. But people have been working there since 1957: they study the climate of the continent, its geology and, of course, drill into the ice of Antarctica
for scientific purposes. In addition, the South Magnetic Pole, which is also an object of study, is located nearby. There is practically no life around Vostok, only trace amounts of microorganisms. During the summer, the station employs up to 50 people, while only 20 call it home during the winter months.
But in 1998, at the 3,623 m mark, the work was stopped. Why? Drillers were using a mixture of aviation kerosene with a special weighting agent, freon , as drilling fluid. The weighting agent is necessary to fully compensate for the rock pressure of the ice mass: without it, the borehole may collapse into itself. Can you imagine what this poisonous mixture would do if it got into the lake? The majority of its unique biota would die as soon as the drill entered the water. That is why, for the purpose of preserving the lake’s ecology, work was suspended for eight whole years, just 150 m away from the lake’s surface. This was on the initiative of SCAR, the Scientific Committee on Antarctic Research. Later, oligodimethylsiloxane silicone fluid compounds came along to help researchers and drillers. This hydrophobic liquid, due to its chemical inertness, is harmless to humans and animals, which means there is a good probability that its effect on the microorganisms of the lake is also neutral. Additionally, the mechanical drill was replaced with a thermal one.
Through the use of radar and satellite that penetrate through the icy depths, over 150 subglacial lakes have been discovered under the Antarctic ice sheet.
OXYGEN CONTENT The water in the lake is fresh, with a very high oxygen content (50 times higher than the norm). Oxygen enters the water from melting ice.
WATER TEMPERATURE At that depth, the temperature fluctuates around 10 °C. The water is presumably heated by underground geothermal sources.
PRESSURE Calculations show that the pressure in the lake is over 300 atm; these conditions are created by the thickness of the ice.
ICE TEMPERATURE DEPENDS ON DEPTH Distance from the surface, m Ice age Warming from bedrock
Modern average surface temperature Little Ice Age
0 — 500 — 1000 — 1500 — 2000 I I I I I I I — 32 –31 –30 –29 –28 –27 –26 Temperature, °С
TEMPERATURE Vostok is located at one of the coldest places on the planet. On July 21, 1983, a temperature of –89.2 °C was recorded at the station, the record low of the 20th century.
AIR Antarctica is one of the driest places on Earth. Therefore, the air near the station has zero absolute humidity and is also strongly ionised. Polar explorers often experience respiratory problems due to low oxygen content.
POLAR NIGHT Lasts for 120 days.
STAFF OF RESEARCHERS During the summer, there are about 50 people at the station, while during the winter months, it is staffed by only 20 scientists and engineers.
Vostok station The 5G drilling complex Engine room Vostok station The 5G drilling complex Engine room The 5G drilling complex Engine room IcemovementdirectionСargo is delivered by plane in summer time; in winter, it is al most impos sible to reach the station
In 1989, a team of research ers from France, the USSR, and the USA began drilling the SG-1 borehole. The aim of the project was to study changes in the Earth’s cli mate.
From 1836–1837 m
From 3050–3051 m
The TBPO-132 creates an additional buffer layer in thaw ing water under an organosilicon wash solution. The density of the liquid in the well had to be lowered so that its pressure was 0.3–0.4 MPa, below the estimated pressure in Vostok. This way, the drilling mud would not enter the lake. The water had to independently travel 30–40 m upwards in the borehole and instantly freeze. It was proposed that the “fresh” relict ice be obtained with the help of a mounted electromechanical drill.
The ice shell on the surface is con stantly forming as snow is com pacted by new precipitation and becomes immersed in lower layers, where it has a granular structure and is located at a depth of up to 54 m. Further on, it becomes denser — in the more recent snow, up to 1,837 m, bands of annual snowfall are clearly visible. At the bottom of the borehole (3,051 m), the ice has impurities of sand and silt. The lower the layer of ice, the more pressure it is under
On November 28, 2011, a new drilling unit arrived at the Vostok Station to undertake its journey downwards. By January 12, 2012, the ice-borer reached a depth of 3,737.5 m, and on February 4, at a depth of 3,766 meters, it came into contact with the surface of the water, thus ending the under-ice lake’s 15 million years of isolation.
Much of this complicated technical operation did not go as planned. In particular, it turned out that the water temper ature in the lake was –2.65 °C, and that the pressure there exceeded 400 atm! Therefore, the water from Lake Vostok rose 600 m through the borehole, mixing with the drilling fluid and freezing. About 30–40 l of water mixed with water-polluting microorganisms was extracted from the surface. A year later, they managed to isolate a 2-m ice core and investigate its compo sition. However, ice in the hole complicated the re-drilling, so on January 15, 2015, scientists made a parallel well and re-entered the relict snow.
Predictably, no dissolved organic carbon was found in the ice, but it was highly saturated with oxygen — up to 800 mg per litre, which is ten times higher than the limit values at which bacteria can survive. Microbiologists had to spend a lot of time isolating the so-called contaminant bacteria that got into the samples as a result of external contamination. But it wasn’t long before they discovered rare species.
A sample of ice from a depth of 53–54 mIn 2016, the staff of the cryobiology laboratory at the Petersburg Nuclear Physics Institute announced the discovery of a microorganism, for now classifi ed by the code w123–10. Around 14 % of this microbe’s genome is composed of unique nucleotide sequences, which makes it possible to classify it as previously unknown. Interestingly, this organism was not the fi rst underwater “alien” to be discovered: in 2004, even at a drilling stage of just over 3 km, Hydrogenophilus thermoluteolus bacteria was found. These organisms are characterised by their unique ability to live at –50 °C. Don’t let the relatively low number of organisms found so far mislead you: to this day, wherever water has been found on Earth, so, too, has life. There are still many discoveries ahead.
Lake Vostok cannot be called unique: in Antarctica, there are well over 400 under-ice reservoirs, though they are much smaller in size. For example, Lake Ellsworth, according to the hypothesis of British scientists, has been isolated from the outside world for more than 125,000 years and is now becoming an important object of research. Water samples from the small subglacial Lake Whillans (just a few meters below an 800 m ice sheet) were collected by US polar explorers in early 2013. It turned out that the lake is inhabited by colonies of microorganisms, whose concentration is only ten times lower than in oceanic water. These bacteria do not get their energy from the Sun, but rather from breaking down carbohydrates.
Decades of research on unique lakes have allowed us to only barely touch the surface of underwater, icy relicts, and these attempts can hardly be called wildly successful. Scientists suggest that if life fl ourishing in Vostok is closer to the bottom of the lake, where
While exploring the depths of the planet, scientists carry out mini-earthquakes of sorts. Typically, these are powerful explosions, the shockwaves of which are directed into the ground. Based on the behaviour of the waves as they travel through rock, we can determine the structure of the crust of the Earth. Seismic survey stations are installed to record the reflected seismic waves, which help us to, among other things, find oil and gas deposits at extreme depths, as well as caves and subterranean lakes. Seismological studies of Antarctica in the late 1950s made it possible to make an important discovery, determining the thickness of the ice sheet, which turned out to range from 2–4 km. This method makes it possible to conduct a fairly accurate reconnaissance, but it is very energy-consuming and expensive. A more modern method is geomagnetic deep sounding, in which a powerful radar “radiates” the Earth’s crust with electromagnetic pulses, recording the signal reflected back. This method, which employs a ground-penetrating radar installed on an aeroplane, was used to determine the true dimensions of the subglacial Lake Vostok.
temperatures are not as low, deep immersion into these subglacial waters could provide answers to many questions, including the possibility of life beyond our planet.
Take Saturn’s moon, Enceladus, for example. It is covered with many kilometres of icy crust. Underneath, there could be a hidden ocean, full of life. And Enceladus is not unique: Jupiter’s moons, Ganymede, Callisto, and Europa are also presumably home to deep oceans. Lake
The extremely weak current in Lake Vostok implies that the floor sediments have stayed unchanged for millions of years. This is a very enticing opportunity for geologists, who could possibly determine the history of the whole continent based on this sediment alone. Its shape and composition can tell us about the climate and movement of Antarctica’s ice sheet. For now, geologists will keep studying the borehole that has already revealed information about the climate over the last 400,000 years!
Vostok can become a model for the development of extraterres trial life. We won’t be able to land on the satellites of Saturn and Jupiter in the foreseeable future, but it is quite possible to penetrate the depths of a terrestrial subglacial lake. This epic of the depths of Antarctica is a remarkable example of cooperation between the international scientific community, where relations between countries and individual people are not overshadowed by military operations or political senti ment. The Scientifi c Committee on Antarctic Research has become a roundtable where leading scientifi c powers share information and synthesise their knowledge on the challenging business of studying Antarctica. We continue to follow the quest of the “lost Vostok”— the future promises to surprise us!
You’re probably familiar with at least one geological period. Who hasn’t heard of the film Jurassic Park? The entire history of the Earth over the past 540 million years is divided into periods, which are in turn divided into epochs and centuries. But how do geologists know when a particular stage started and ended?
How can we even begin to understand what was happening on our planet millions of years ago? Our main source of information is rock formations that developed during those distant eras. By studying them, geologists can try to reconstruct the conditions that existed at the time of their formation. For example, if a layer of solidified lava or volcanic ash is found, it is evident that a volcano was erupting nearby. A layer of clay suggests that there was a sea, and quite a deep one. In addition, fossilised remains of ancient animals and plants are often preserved in sedimentary rocks, which can be used to restore their appearance.
If we find a place where several di erent layers are visible one above the other (this is called a geological outcrop ), then it is logical to assume that the higher up the layer, the later it was formed. This method was applied in the 17th century by the Danish scientist N S (also known as Nicolaus Stenonius or Nicolas Steno) — today, this idea is called Steno’s law of superposition . Based on it, you can determine the relative age of rocks that are in one place; that is, we can understand which rocks formed earlier and which formed later. However, this does not help us to determine how many millions (or maybe thousands? or billions?) of years ago they appeared: their absolute age.
Younger layers of rocks are located on top of older ones
Layers of sedimentary rocks are initially flat, parallel to the horizon
Rock layers are continuous until they collide with other solids that block their deposition, or until they are affected by agents that appeared after deposition occurred T
Rock layers A and B must be older than the intruder C
Can we compare the ages of rocks from di erent outcrops? It is clear that if the layers are located close to each other, at a distance of only several kilometres, then the rocks contained in them will most likely be very similar, if not identical, so it will not be di cult to compare them. But if the outcrops are located hundreds or thousands of kilometres from each other, or even on di erent continents, the rocks in them are likely to be di erent, and direct comparison will be impossible. A way to solve this problem was proposed in 1799 by the British engineer W S
Geological outcrops in Karijini National Park, AustraliaWorking on the construction of canals in di erent parts of England, he noticed that the findings in rock layers exposed by canal excavations did not occur randomly. Each rock layer is characterised by its own set of fossils — the mineralised remains of organisms and traces of their life activity.
Moreover, the order of these sets of fossils is the same in di erent places. When Smith decided to classify rock layers based on these sets of fossils (which is why they are called index fossils ), it turned out that the vertical sequence of the layers is the same everywhere. He then assumed that layers with the same index fossils were formed at the same time, and he combined layers from several di erent outcrops in one diagram.
As a result, he obtained a framework for the sequence of layers with the same index fossils (geologists call them strata ) — a geologic time scale. Each layer corresponds to the time interval in which it was formed. Based on this finding, Smith made a geologic map of England and Wales in 1815 (this was the first time in history that such a vast territory was mapped by geologists). The map looked
very modern: it displayed the distribution of rocks on the surface, with rocks of the same age represented by the same colour.
Over the next two and a half decades, geologists systematised the geologic time scale, identifying large geological layer systems and their corresponding time intervals, periods . By 1841, almost all the existing periods had been determined. Their names are derived mainly from the names of localities where the corresponding deposits are widespread. Thus, the name of the Devonian Period comes from
Diagram for building a geological cross-section across multiple outcrops
the County of Devonshire in England; Permian from the city of Perm in Russia; and the Jurassic from the Jura Mountains on the border of Switzerland and France. In some cases, names of characteristic rocks were used.
For example, there are many coal beds in the Carboniferous deposits, and chalk deposits in the Cretaceous. By the end of the 19th century, the periods were grouped into three eras — the Paleozoic, Mesozoic, and Cenozoic, and divided into smaller parts: epochs and centuries.
However, it remained completely unknown how long ago all these periods took place and how long they lasted. There have been attempts to estimate the rate at which precipitation accumulates in modern seas and, based on this value, to calculate the length of periods during which layers of known depth have accumulated. However, this is a very slow process — usually, over the course of 100 years, not even a whole centimetre is deposited; and in addition, over time, precipitation is strongly compacted (though it was not yet known by how much). So, this method did not provide us with any reliable data. Therefore, scientists relied mainly on estimates of the total age of the Earth and then tried to calculate the length of each period, assuming that its share in the total history of the Earth is proportional to the share of the corresponding deposits in the combined section. The problem was that it was also impossible to determine the age of the Earth very accurately. For example, in 1868, the British physicist W T (who later received the title of 1st Baron Kelvin for his scientific achievements), based on a mathematical model, suggested that its age is 20–40 million years — during this time, the once-hot planet would have cooled to its present temperature.
An imprint of a Dickinsonia , a genus of animals that lived in the Ediacaran (the last Precambrian period) in the seas to the south of modern Australia
Sometimes entire “pages” of Earth’s history are lost due to rock erosion or other factors. For example, the neighbouring layers of sedimentary rocks of the Grand Canyon vary greatly in age. The lower formations belong to the Precambrian, while the upper ones belong to the Paleozoic era. Almost a billion years have been “lost!” This phenomenon is
This model did not take into account many parameters, so it is not surprising that the result was incorrect — more than a hundred times younger than the current estimate! But until the end of the 19th century, this value was accepted by most scientists. It is clear that the length of geological periods based on this figure were also greatly underestimated.
In the 19 th century, the geologic time scale was designed only for rocks that were formed no earlier than the Cambrian period. In the previously-formed rocks, it was absolutely impossible to find not only characteristic sets of fossils but any traces of life at all, which means that the principle of combining layers according to the index fossils, as developed by Smith, did not work. In the 20th century, traces of life in Precambrian deposits were found, but the Precambrian periods are still mainly distinguished not by characteristic sets of fossils but by the results of absolute dating.
Paleozoic ≈ 252–541 million years
Paleoproterozoic ≈ 1.6–2.5 billion years
Archaean > 2.5 billion years
Limestone Shale Sandstone Composite rocks Colorado riverPLANET EARTH
LAW OF RADIOACTIVE DECAY
Amount of radioactive substance 1 2 3 4
The situation changed when the French chemist Henri Becquerel discovered the phenomenon of radioactivity in 1896. In 1904, the British physicist E R discovered that radioactive isotopes have a certain period of time, independent of external conditions, during which half of their initial amount decays, and he called it the half-life. At the same time, he proposed the idea of radiometric dating . This technique is based on the fact that if a mineral contains a radioactive isotope, by determining the ratio of the mass of this isotope to the mass of the isotope formed as a result of decay, you can calculate the time of formation of the mineral.
The first experiments in radioisotope dating, conducted independently in 1907 by Rutherford and the American radiochemist B B, although very inaccurate, still proved that there are minerals on Earth that are at least two billion years old, and therefore the planet itself can be no younger. In the following years, dating technologies further developed, and in 1956, the age of the Earth was determined to be approximately 4.54 billion years — since then, this estimate has not changed much.
It would seem that radiometric dating would allow you to determine the
age of not only the Earth but also any rocks that contain radioactive isotopes. However, the age of a rock rarely coincides with the age of its constituent minerals. For example, a layer of sand may have been deposited ten thousand years ago, while the grains of quartz that make it up were formed millions or even billions of years ago. Therefore, only those rocks that were formed simultaneously or almost simultaneously with the minerals that make up their composition are suitable for radiometric dating — that is, igneous rocks that arose as a result of the cooling and solidification of magma or lava.
At the same time, the geologic time scale is based, as you already know, on the order of sedimentary rocks. Therefore, geologists usually follow this procedure: find a layer of igneous rock lying between two successive strata of sedimentary rocks and date it, thus determining the absolute age of the boundary between these strata. By now, all borders have been dated using this method, not only between periods but also between the epochs and centuries that make them up. But due to the fact that dating is constantly being refined, geologists still prefer to use relative rather than absolute age.
Precambrian
GEOLOGIC TIME SCALE
Eon Cenozoic
Era Quaternary 2.58
millions of years ago Neogene 23 Paleogene 66 Mesozoic Cretaceous 145 Jurassic 201 Triassic 252 Paleozoic Permian 299 Carboniferous 359 Devonian 419 Silurian 444 Ordovician 485 Cambrian 541
Ediacaran 635 Cryogenian 720 Tonian 1 Mesoproterozoic
Ectasian 1.4 Calymmian 1.6 Paleoproterozoic
Statherian 1.8 Orosirian 2.05 Rhyacian 2.3 Siderian 2.5
Stenian 1.2 billions of years ago
Archean
Neoarchean 2.8 Mesoarchean 3.2 Paleoarchean 3.6 Eoarchean 4 Hadean 4.6
The Phanerozoic Eon (which began 541 million years ago and continues to this day) is the largest interval of geologic time. It is famous for its abundance of living organisms, the components of fossils in sedimentary rocks.
The boundaries between successive strata look slightly different in di erent outcrops: after all, strata may be composed of di erent rocks, and the set of fossils varies slightly from place to place. Therefore, geologists agreed to find a section for each boundary between strata in which it would be most noticeable, called the stratotype. When you highlight the boundaries between strata in other outcrops, the stratotype is used as a reference. Dating
Methods
Description
Steno’s Laws, palaeomagnetism, palaeopalynology (the study of fossilised pollen), nitrogen dating, etc. Radiometric, uranium-lead, optical, thermoluminescent, archaeomagnetic dating, dendrochronology, etc.
Relative dating methods cannot determine the absolute age of an object or event, but they can determine whether event A occurred before or after event B.
Absolute dating methods using absolute referent criteria mainly include radiometric dating methods.
The Quaternary Period began 2.6 million years ago, and it continues to this day. Until recently, geologists divided it into two epochs — the Pleistocene, which covers almost the entire period, and the Holocene, which began only 11,700 years ago. However, in 2016, delegates of the 35 th International Geological Congress, held in Cape Town, voted to allocate a
new epoch — the Anthropocene Their main arguments focused on the sharply-increased impact of human activity on Earth, which is expressed in the mass extinction of species, global climate warming, and environmental pollution, including substances not found on Earth in nature (plastic, aluminium, reinforced concrete). As a marker of the transition to a new era,
it was proposed to designate the sharp increase in radioactive isotopes in sediments around the world, associated with the beginning of nuclear testing.
Thus, for the beginning of the Anthropocene, you can specify the exact date of reference: July 16, 1945, when the first nuclear bomb was detonated at the Alamogordo test site in New Mexico.
Crushed stone and asphalt are typical deposits of the AnthropoceneScience and technology don’t stand in place: scientists around the world work to ensure that the production of fresh and healthy foods is simple, cost-effective, and environmentally friendly. So, in place of classic garden beds and greenhouses comes hydroponics: growing plants in nutrient solutions without soil.
The idea of growing plants without soil is not new. Back in 1699, the English naturalist J W described his experiments growing peppermint in a soilless environment. The plant died in desalinated, distilled water, but it continued to grow in untreated water. Probably, Woodward reasoned, the mint extracts something from the water that is necessary for growth.
Now we know that the plant needs many mineral substances for normal growth and development, including calcium (Ca ), iron (Fe ), potassium ( K ), magnesium ( Mg ), phosphorus (P ),and sulphur (S ). Plants take them from the soil (some predators, like Venus flytraps, get them from the bodies of their victims), but for this, there must be water in the soil to dissolve the mineral substances, making them accessible to the roots. Plants don’t need the soil itself, they just require mineral substances from it. Woodward’s experiments gave rise to much reflection, but, until the beginning of the 20th century, the cultivation of plants without soil remained an area of exclusively scientific interest.
Woodward’s experiments gave rise to much reflection, but, until the beginning of the 20th century, the cultivation of plants without soil remained an area of exclusively scientific interest.
In the 1930s, American biologist W F. G brought hydroponics out of the laboratory and into the light. He insisted that growing plants on a large scale without soil, but instead on nutrient solutions, is not only possible but also makes a lot of sense. His colleagues were sceptical about this idea at first, but when Gericke showed them tomato shrubs a few metres tall that were grown with an aqueous solution of mineral substances, they changed their mind. The University of California, where Gericke worked, even allocated huge areas for such experimental greenhouses. He called his revolutionary method “aquaculture,” but there was some confusion: the word was already in use for the breeding of aquatic organisms (fish, algae, molluscs). It was then that he introduced a new term — hydroponics — which we still use to this day, as it carries the understanding that this is the cultivation of plants using nutrient solutions and without soil.
diy
The first mention of the commercial use of hydroponics was in 1938 when Time magazine published an article about tiny Wake Island in the Pacific Ocean, where Pan American Airways planes landed for refuelling. Among other things, the article said that barrels with mineralised water, in which beans, toma toes and other vegetables were grown, were installed on the island. This food was intended for the aircraft crew. During World War II, there were more of these kinds of farms: the military needed fresh vegetables and it was difficult to deliver them. Today, hydroponics is widely used all over the world. For example, NASA is studying the possibility of growing vegetables on a spaceship in a closed ecological life-support system. The suc cess of such an experiment will lead to new prospects for space travel.
Humankind has been growing fruit and veg etables for thousands of years. Why spend money on technological development when you can just stick a plant in the ground? Because hydroponics has a lot of advantages. It gives us the opportunity to grow food in places where traditional agriculture is impossible. In arid climates, like Israel and Egypt, hydroponics has been used for several decades. Thanks to this method, it became possible to pur chase locally-produced food on the mar ket, rather than importing these products from other countries at a high cost. Sim ilarly, hydroponics are needed where space is limited, even for humans. For ex ample, in Bermuda, these systems occupy only 20 % of the amount of land that would be required for crops. In regions that are cold and have few sunny days, hydroponics allows you to harvest a high
The idea of hydroponics is that soil is not an obligatory companion of plants, but is rather just support for it. Therefore, the substrate can have many dif ferent compositions — coconut fibre, sawdust, mineral wool, crushed stone, expanded clay, etc. It is only important that it conducts moisture well, allows air to circulate, and does not chemically react with the nutrient solution. By the way, moist air can also serve as a substrate (this is called aeroponics).
yield of local vegetables and fruits. In cit ies with poor ecology, the cultivation of plants without soil solves several prob lems at once: greenery appears, which is typically rare in densely built-up areas, and along with it, food products start to grow in homes and offices, which leads to almost unlimited access to fresh, healthy food. The critical argument in favour of hydroponics is the high environmental friendliness of this type of agriculture. The water circulates in a closed system: it passes through purification systems, is enriched with nutrients, and again flows to the plants. This is extremely impor tant for areas where there is little water, such as in the Middle East and parts of Africa. Besides, almost no pesticides are required: the conditions on farms are practically sterile, and hydroponics re quire only about 25 % of the amount of fertiliser necessary for growing plants in soil. This approach saves money and con tributes to the preservation of the envi ronment. Finally, since the food is grown on-site, there is no need for it to be trans ported — again, both the producer and nature benefit.
NASA is studying the prospects of growing vegetables in space
Hydroponic farms are similar to conventional greenhouses, but instead of beds, there are special shelves, under which grooves with nutrient fluid are located. Seeds are kept in a special incubator until the fi rst shoots appear, and only then are they sent to the hydroponic farm. Since the roots of plants are immersed directly in the nutrient solution, vital substances do not need to break through the soil layers, the root system grows minimally.
Thus, all organic substances synthesised by the plant go to the construction of shoots, leaves, and fruits. Under such conditions, the plant grows extremely quickly: a salad bush on the soil bed grows in a couple of months, while in a hydroponic farm, it takes only 30 days. To obtain a large crop, it is not enough to just provide plants with nutrients. The growth of crops is affected by many factors that need to be kept under control. To do so, dozens of sensors are installed in the greenhouses: they monitor the acidity and electrical conductivity of
water for irrigation, ambient temperature, humidity, brightness, and CO supply.
Well-designed heating systems located near the plants create a uniform temperature regime around the plant and enhance gas exchange. Artifi cial lighting allows you to control the development of plants, to accelerate or slow down flowering, and to affect the maturation process. All you have to do is extend daylight and the development of long-day plants will accelerate, which means that the harvest can be collected
much earlier. Knowing exactly how each part of the light spectrum operates on cultivated plants, scientists and engineers have created phytolamps that emit light in the red and blue regions of the spectrum. Conditions are created to enable the maximum intensity of photosynthesis, and plants begin to grow faster. The conditions in the greenhouses are so conducive to growth that the plants grown in them are always beautiful, bright, and juicy, just like in the pictures.
Ripe strawberries grown in hydroponic farms are an object of agricultural tourism in Israel. Tourists can take part in harvesting at any time of the year.
In the near future, the growth of the world’s population will lead to a shortage of arable land.
Vertical farms allow us not only to abandon soil but also to use space economically, placing hydroponic installations in several tiers.
A reusable substrate is used
CONTROL
The composition of the nutrient solution can be changed
Does not require special skills or knowledge
SIMPLE TECHNOLOGY ECO-FRIENDLY
Small quantity of fertilisers and pesticides
Fast growth in any season
Through water reuse
#1 dECEMBER 2020 47
• A planter (must be opaque; otherwise algae will start to grow and not let water pass through)
• An inner plastic pot with drain holes (to allow air and nutrient solution in); it should be able to sit “suspended” in the outside pot
• A substrate of expanded clay (you can buy this in a flower shop)
• A hydroponics nutrient solution (you can buy this in a flower shop as well)
• Clean, room-temperature water
●
The day before the transplant, water the plant well. Thoroughly rinse the roots with warm water, so that they do not have any soil left on them. Remove rotten and damaged roots.
1 ● 4 ● 2 ● 5 ● 3 ● 6
Place the inner pot inside the external one and pour clean, roomtemperature water into the outer pot. If you immediately pour a nutrient solution, the plant will be under stress and may die.
Insert the indicator into the inner pot.
Spread the roots of the plant and surround them with expanded clay.
Put the pot in a warm and bright, but not very sunny place. In a week, the plant can be watered with a solution for hydroponics until the liquid fills one-third of the inner pot. When adding the nutrient solution, watch the water level on the indicator.
From the first antibiotics to the growth of stem cells, from observing microorganisms to the testing of new medicines — it’s all possible thanks to the Petri dish, a short, flat cylinder covered with a transparent lid of a corresponding shape. This humble glass plate has its own fascinating story.
In 1872, ROBert KOCH , who would later become a renowned microbiologist, was named the District Medical Officer in Wollstein (now Wolsztyn in Poland), where an anthrax outbreak was running rampant at the time. The disease was known even back in antiquity when it was called “sacred fire”: people thought that only furious gods could have sent such a scourge to Earth. Anthrax was a threat to all agricultural settlements — more often than not, livestock were infected. However, animals were not the only ones to die: the illness also claimed the lives of farmers, shepherds, and milkmaids.
Looking through a microscope at the blood of the deceased animals, Koch discovered that the development of the disease could be blamed on a single Bacillus microbe (Bacillus anthracis). The researcher successfully isolated the bacteria and was able to grow a pure culture from it — a culture that is composed of a single type of microbe. He infected an entirely healthy animal with this pure culture, thus giving it anthrax. The scientist understood that the creation of a pure culture was the key to successfully determining the cause of an infection.
Koch, like his predecessors, developed bacterial cultures in a liquid medium, broths made of meat or cereal grains. Koch did manage to create a pure culture of Bacillus anthracis in a liquid broth, but he was still searching for another method, and with good reason. If several species of bacteria happened to get into the broth, they would mix together, making it extremely difficult to separate them. It was necessary to develop the bacteria more than once. Koch would take a small drop from the solution where the target bacteria were in the highest concentration, and then he would transfer it to a fresh broth. In this new broth, there were already fewer foreign bacteria, but he had to repeat this monotonous operation several times to achieve a monoculture of a single species of microbe in the growth medium.
Microbes are very small (0.5–5 microns on average) and do not differ much in appearance, which causes difficulties in studying them. For research, it is necessary to single out one microbe from the surrounding world, which is filled to the brim with radically different microorganisms. Microbial cells, after landing in the growth medium, produce offspring — a cluster of identical cells called a colony, which can be studied like a single microorganism. It turns out that, by manipulating the conditions of cultivation, it is possible to obtain a pure form of the cells of any microorganism. Thereafter, you give it a name, describe its properties, and classify it. Thanks to Koch’s discovery, microbiology has been recognised as a science in its own right.
K (1843–1910) was a German microbiologist. He discovered Bacillus anthracis, Vibrio cholerae, and Mycobacterium tuberculosis (Koch’s Bacillus). In 1905, he was awarded the Nobel Prize in Physiology and Medicine “for his investigations and discoveries in relation to tuberculosis.”
Before Robert Koch, researchers believed that microorganisms were colourless, which led to numerous mistakes. Koch used aniline dyes, which selectively stained microbes. After Koch’s experiments, researchers around the world began to use this technique of dyeing bacteria. Then, in 1884, Dr H C G developed a method of staining that became the primary approach to determining the presence of a type of bacteria in a given substrate.
After his report on the discovery of the agent that causes anthrax, Robert Koch was invited to head a laboratory at the Hygiene Institute in Berlin, and he was offered the post of Advisor to the Imperial Health Office. Koch suddenly had good equipment, talented assistants, and the ability to solve a mystery that had long haunted him. It was known that tuberculosis was also caused by some kind of microbe: the tissues of a sick person could infect healthy animals. Koch managed to find a technique for staining prepared tissues to discern the pathogen bacteria under a microscope. But his joy didn’t last for long — the bacteria did not want to grow in normal growth media.
One day, the scientist noticed that a pile of mouldy potatoes left on the table had an abundance of coloured spots— colonies—of grey, yellow, and green. He collected samples from each colony,
Koch’s accidental observation fomented a revolution: fresh potatoes became one of the first solid media for cultivating microorganisms. How ever, such a nutritious substrate was not suitable for all microbes, and, there fore, the search for an alternative solid medium continued.
A macro image of Mycobacterium tuberculosis colonies. They are distinguished by a colourless, uneven surface.
Microorganisms divide approximately every 20 minutes, and therefore, only three hours after transplanting a microbe into a Petri dish, you may already see colonies. Within 24 hours, the number of bacteria is estimated to already be in the millions.
and he noticed under the microscope that each spot was a colony of a single species of microbe! In liquid media, the microbes mixed and separated, making them extremely diffi cult to work with. But in a solid medium, they stayed in a single spot, multiplying and giving birth to a pure culture!
Koch once again began to diligently cultivate tuberculosis cultures. Yet, the bacteria did not grow on the potato slices. He then began to use gelatin to turn the broth into a solid growth medium . After many unsuccessful attempts, Koch added blood serum to the substance to recreate the con ditions of a living organism. After 15 days (it had never taken that long for Bacillus anthracis), droplets of colonies of the dan gerous Mycobacterium tuberculosis began to appear on the surface of the medium.
British bacteriologist Alexander
Fleming , who discovered penicillin, also created a new art form: drawing with bacteria on a solid growth medium. Fleming, as a member of the Chelsea Art Club, created “amateur” watercolours. The scientist painted graceful ballerinas, luxurious homes, soldiers, and other scenes using bacteria. The creation of a painting required patience: one needed not only to find bacteria of various pigments but also to calculate the time
In 1928, the British bacteriologist Alexander Fleming discovered that in the agar in one of his Petri dishes, a colony of mould fungi had grown next to bac t eria. Bacterial colonies around the mould turned pale: their cells had been destroyed. Fleming isolat ed the substance destroying the bacterial cells — penicillin, the first antibiotic created from mould. Fleming’s discovery changed not only medical science but also the fate of many would be hopeless patients.
of cultivation so that a monochromatic area would grow simultaneously and not blur the lines between colours.
The American Society for Microbiology (ASM), inspired by Fleming and his colleagues, has held an “Agar Art Contest” every year since 2015. Talented microbiologists paint real pictures, some choosing their own subjects, while others reproduce famous paintings with astounding accuracy, such as Van Gogh’s Starry Night.
At that time, the only piece of laboratory glassware that was suitable for growing microbes was a test tube. But handling it required skill: if you laid the tube horizon tally, the unshielded medium would pour out; if you put it at an angle, it could fall and break. Your chances of catching a dangerous disease literally multiplied before your eyes! Then, Koch and his laboratory assistants came up with the idea of housing growth media in cups covered with high glass caps. But to observe the colony, you had to remove the cap, which was a surefire way to catch the infection. That’s when one of the lab oratory assistants, Julius Petri, had his moment in the sun. He reduced the height of the walls of the cup in which the mi crobes were developed and covered it with another transparent cup. This made it far easier to observe the colonies.
Petri worked under Koch’s leadership for only a couple of years (1877–1879), but in that time, he radically influenced the future of microbiology. Petri’s inno vation gave medicine a powerful push and saved millions of lives. After his work with Koch, he went on to head the Gobersdorf Sanator ium, the first Euro pean center for treating tuberculosis patients.
Koch’s laboratory did not just produce the Petri dish but also the standard filling for it, the agar growth medium. Its predecessor, the gelatin medium, melted easily
when heated or kept in a warm place. In that environment, the colonies literally turned into a hot mess.
Walter Hesse , another laboratory assistant of Koch’s, invented the medium that became the basis for agar. He joined the ranks along with his wife, FannY Hesse , who was not a laboratory employee but worked as a scientific illustrator, sketching the organisms that she saw under the microscope.
One day, Fanny prepared some jelly at home, and Walther noticed that it did not lose its shape or melt in the sun. He found out that the main component of jelly is
agaragar, a substance extracted from red and brown algae. Walther replaced the solid gelatin with this substance, and the bacterial growth media became firmer. Agar is used today for medium preparation, but it is purified with a special technique.
At first, the Petri dish was only used for growing cell cultures, but now it is widespread across many fields of science. For example, Petri dishes are used to
To determine the effectiveness of antibiotics in the pharmaceutical industry, special tests are used — for example, agar diffusion. In this method, microorganisms are set into Petri dishes and then antibiotics in various doses are placed on the surface at an equal distance from one another. The larger the radius of the inhibited growth zone, the more effective that medicine will be against the microorganism.
study the effectiveness of antibiotics, the safety of different foods, and to develop geneticallyengineered bacteria that synthesise insulin, a substance necessary for individuals with diabetes.
Petri dishes are made in different sizes and from a wide variety of materials: glass, plastic, and even stainless steel. All a scientist has to do is pick the one appropriate for their work.
On August 16, 1858, Queen Victoria sent a telegram to James Buchanan, then-President of the United States. For the first time in history, high-ranking o cials communicated via transatlantic telegraph cables. The process took almost 18 hours. Today, it would take you no more than 70 milliseconds.
Contemporaries celebrated the event as epoch-making. The press on both sides of the Atlantic competed to express their enthusiasm, practically equating a few telegram messages to the discovery of a new continent. The celebration, however, turned out to be premature: cables that had been laid only after a third attempt broke down after a little more than a month. Only 732 messages were sent via its copper wires. From the point of view of modern volumes of information transfer, this was but a speck of dust — but that was only the beginning! Even then, it was obvious that communication cables would soon be the “backbone” of the infrastructure of the coming epoch. And the future came so suddenly that today, installations of new cables, grandiose in their capacities, are taken for granted and don’t spark much public interest.
The first cable establishing a direct connection between Virginia Beach and Rio de Janeiro offers the lowest latency available today. It was designed specifically to minimise risks in the event of natural disasters.
In February 2018, the Spanish company Telxius began data transmission along the Marea cable (from the Spanish marea , “tide”) — an undersea cable connecting Virginia Beach on the East Coast of the United States with Sopelana, a town near Bilbao in Spain. Another cable? The total length of underwater communication cables only recently reached 1.5 million km, and there are no more than 500 of them overall (excluding military cables). What is so interesting about this project, then? Well, for one, we can use it to understand the principles and logic behind the installation of undersea cables.
To some degree, this cable can be called a corporate project: it was started by Microsoft, who later partnered with Facebook and the giants of the telecommunications industry, AT&T, Sprint, and Telefónica (Spain). The total cost of the project was more than $15 billion. For a 6,600 km-long cable, the price for each kilometre is more than $2 million. For comparison, the cost of optical fibres for data transmission doesn’t exceed $10! So, what makes it so expensive? Well, the di erence between glass fibre and a communications cable is similar to that of a spool of thread and an evening gown by a high-fashion designer.
The list of requirements for an undersea cable is not very long, but the demands for each item border on the extreme. The cable, of course, has to be durable; it must be waterproof along its entire length (Marea’s maximum burial depth was 5 km, where the pressure reaches 500 atm); and it must have su cient mechanical strength for installation and operation. The most critical factor is that its working characteristics must
remain unchanged throughout its 25-year design lifespan. The inner part of the cable doesn’t contain anything special — it’s just a bundle of fibre-optic cables, in which the core and the cladding have di erent refractive indices: higher on the inside and lower on the outside. A light pulse travels through the fibre, repeatedly reflecting o the border between the surfaces, and becomes subject to total internal reflection . Because the movement takes place inside an optically dense environment, the speed of signal transmission is 40% lower than the speed of light in a vacuum.
The bulk of a cable’s cost is due to its multiple layers of protective mechanisms. The first barrier against seawater is polyethylene, an insulating material that has become traditional. It is water-resistant and does not react when it comes into contact with di erent concentrations of alkali, salt solutions and acids, which are abundant in seawater.
However, polyethylene is permeated with tiny pores; therefore, sooner or later, the water breaks the barrier, and there it is met by a film of BoPET (also known by the brand name Mylar) — a synthetic material made from polyethylene terephthalate that is currently used in the production of all kinds of things, from underwear to sails and parachutes. Sometimes, Kevlar fibres are also added to the protective layer.
But that’s not all. The next layer is composed of stranded galvanised steel wires that provide the cable with su cient hardness and resilience. It acts as chainmail of sorts, protecting the cable from tears by anchors and trawls, attacks by toothy sea creatures, as well as the hostility of opponents to technological progress (true story!).
There are lots of interesting things underneath the steel armour: polyethylene-aluminium, a “sandwich” made of a metallic foil and polymer fi lm; resilient polycarbonate that provides the cable with an additional safety margin and, finally, a copper or aluminium tube filled with a water-repellent gel. Now, we’ve reached the most important part: inside this gel are the thin-walled, small-diameter copper tubes, through which the optical fibres are run.
Copper elements don’t simply reinforce the cable and shield it from outside interference. They also conduct current to control nodes and repeaters, which are responsible for the laser retransmission of an attenuated, modulated beam that passed through a previous cable section, as well as error control. The average distance between repeaters is 100 km, so cable damage can be localised with good precision fairly quickly.
Optical fibre is an optically transparent material, usually plastic, through which pulses of light (or information) travel. In this process, the e ect of total internal reflection against the cable’s walls is used. This is why the signal doesn’t attenuate and maintains a high speed when transmitted over long distances.
With a 6,600-km length and a 200Tbps capacity, this transatlantic cable has the lowest latency and the highest capacity available today
A transatlantic cable’s weight per running meter can reach up to one tonne, but usually, the only fragments that are encased in extreme protection are those laid down at coastal and shallow-water areas. At great depths, where the e ects of human activity are not as significant, there is no point in increased protection; therefore, a lighter, water-resistant cable with a diameter of 2.5 cm is laid there, instead.
Still, the total weight of a cable running thousands of kilometres long reaches a few thousand tonnes. For example, Marea totalled at 4,600 t! Transporting such a delicate and bulky load is obviously not a simple task. Construction workers took a radical approach to this problem: the Spanish company Sanjo, specialising in the manufacture of fine blanking parts, built a small plant in Virginia Beach. The cable was constructed from ready-made fragments into long, multi-kilometre lines, which were then transported onto cable-laying vessels straight from the factory. This decision helped avoid the damage that occurs over ground transportation.
Couple that with the geological and oceanographical investigations required for route planning, the cost of renting and renovation of specialised vessels, and the construction of terrestrial infrastructure … Perhaps, the cost of Marea doesn’t seem so fantastically high to you anymore! Additionally, you have to develop the shortest route (requiring less cable) that avoids hazardous conditions like seismic and volcanic activity, mudslides, and landslides, etc. At the same time, you have to take into account the depth and topology of the seabed, the density and stability of the soil, and many other factors. All of this takes time. Even such authoritative players like Microsoft and Telefónica spent an entire year on preparations — and twice as long to actually lay the cable.
As the jet plow moves along the seabed, it liquefies the soil in front of it using powerful water jets
So, what was all of this e ort for? On the one hand, it gave us a record bandwidth of 160 Tbps, allowing you to download all eight seasons of Game of Thrones in Ultra HD-quality (around 2.5 Tb) in less than 0.2 seconds, for example! In reality, however, all this power is spread over eight streams that correspond to fibre-optic pairs: both Facebook and Microsoft own two pairs, while the remaining four belong to Telxius.
Virginia Beach Sopelana MAREAThis cable is a joint project by the two largest telecommunications companies of Latin America, whose goal is to improve global communications. The cable is expected to begin operation in 2021.
Another motivation behind designing Marea was Hurricane Sandy, which hit the East Coast of the US in 2012. Afterwards, F (F) R, director of global network strategy at Microsoft, explained this decision as follows: “It was a major disruption. The entire network between North America and Europe was isolated for several hours. For us, the storm brought to light a potential challenge in the consolidation of transatlantic cables that all landed in New York and New Jersey.” In other words, a bundle of geographically proximate communications is not the most reliable solution. You need to have high-capacity networks with enough redundancy and contingency, removed from each other at a su cient distance so as not to be damaged by natural disasters.
There are many examples of this. In July 2005, a portion of a submarine cable connecting Pakistan with the grandiose 39,000-km communications system SEA-ME-WE 3 (South-East Asia, Middle East, Western Europe), spanning across Western Europe, the Middle East, the Indian subcontinent, and countries of the Pacific Rim broke down. More than 10 million Internet users were cut o from access to the World Wide Web because of this cable failure.
Especially amusing was one event that led to a dramatic speed decrease in Vietnam’s Internet connection in March 2007. Fishermen managed to steal 11 km of cable from the TVH system connecting Thailand, Vietnam, and Hong Kong. The thieves tried to sell 100 t of fibre-optic cable as scrap, clueless about its real cost. It took three months of repair work to restore the cable to normal operation. Meanwhile, the earthquake and tsunami in Japan that took place on March 11, 2011, damaged the undersea cables that connected the islands with the rest of the world, including the APCN-2 system — an intra-Asia submarine cable system linking China with Hong Kong, Japan, South Korea, Malaysia, the Philippines, Singapore, and Taiwan;
On average, more than 100 faults occur every year. We rarely hear about them because many companies that use cables take a “safety in numbers” approach: they spread their networks’ capacity over multiple cables. In case one of the cables breaks, the network functions smoothly over other cables while the damaged cable is repaired.
as well as the newly-built Unity/ AC-Pacific system laid down by Google to connect Japan and the US.
In addition to telecommunications companies, behind most of today’s major data transfer projects are Google, Amazon, or Facebook. It’s an investment “with room for growth,” based on projected increases in the number of Internet users and a steady rise in data consumption.
Paradoxically, astronautics, the most technological of all industries and one that has become a symbol of progress, is currently experiencing a dry spell. It’s not due to a lack of resources or money but the lack of a grandiose goal towards which we all can collectively strive.
Perhaps there are some sort of fundamental limitations that are getting in our way?
At the dawn of the space age, it hardly occurred to anyone that, just half a century later, society would feel quite the opposite about space exploration: “Why do we need space, anyway? There are already a lot of problems on Earth that urgently need solutions!” To understand the level of enthusiasm and scale of humanity’s hopes at the time, we suggest looking back at the predictions of the legendary futurist and writer ARTHUR C. CLARKE , made in 1999: in 2014, no orbital hotels were opened; in 2015, we still hadn’t invented technology for transmuting chemical elements; in 2020, we haven’t yet managed to launch an automated probe to Proxima Centauri, the nearest star to the Sun; and in 2021, it is unlikely that we will land on Mars. Since the previous forecasts have fared so dramatically, we shouldn’t expect any solar-powered aircraft for interstellar travel by the end of the 21st century.
In reality, over the past six decades of the space age, there have been no qualitative leaps forward in space flight technology. The modern field of astronautics cannot boast of anything so impressive in terms of innovation and significance as, for example, the breakthrough of jet propulsion in aviation in the 1960s. In fact, so far we’ve only managed to more or less master near-Earth space by using developments from half a century ago.
"I am sometimes asked who I would like to remain in the memory of people: a writer, an explorer of the underwater world, a space expert or a populariser of science. Most of all, I would like to be remembered as a writer — one who not only entertained readers but also, I hope, expanded their imaginations."
Sir Arthur Charles Clarke (1917–2008) was a British writer, scientist, and futurist. Together with Stanley Kubrick, he worked on creating the script for the cult film 2001: A SPACE ODYSSEY. Arthur C. Clarke along with Isaac Asimov and Robert A. Heinlein are known as the "Big Three" of the science fiction genre of English-language literature.
Long-distance flights are even worse. The planets closest to us, Mars and Venus, are extremely inhospitable. The budget for just one human flight to Mars, according to experts, starts at $400 billion. It’s difficult to imagine how much it would cost to transform an entire planet. Most importantly, is it even possible in the case of Mars? It is unlikely that humanity would be willing to pay such a price for the development of the “red planet.” It might be a different story, however, if there were a planet that was already habitable.
Arthur C. ClarkeOr maybe you recall the very same Arthur C. Clarke’s Second Law ? “The only way of discovering the limits of the possible is to venture a little way past them into the impossible.” Maybe we should try to engage humanity in a more ambitious task and venture beyond our tiny home, minuscule on the scale of the universe. How about our Solar System?
In 1992, ALEKSANDER WOLSZCZAN and DALE FRAIL were the first to discover planets outside of our Solar System (they are called exoplanets , from the Greek exo , meaning “outside”). Two planets were found near a radio pulsar — a wildly rotating neutron star that spits out enormous energy and bears little resemblance to our Sun. Any object near such a star is obviously uninhabited.
Scientists then posed the question: do star systems have planets similar to the Sun? We didn’t have to wait long for an answer. In December 1995, the star 51 Pegasi in the constellation Pegasus, 50 light-years away, drew the attention of Swiss astrophysicists MICHEL MAYOR and DIDIER QUELOZ . An object impacted it, causing a change in its movement. The explanation was found: a massive planet, similar to Jupiter, orbits the star, only it is twice as light and has a surface about 1000 °C hotter. Since then, a real hunt for exoplanets has commenced. To date, the existence of more than 4,000 planets outside of our Solar System has been confirmed.
Thus far, 4,183 exoplanets have been discovered by astronomers.
Outside of our Solar System, 3,163 known stars have exoplanets, and 701 of them have entire planetary systems.
Fifteen light-years from the Solar System lies one of the closest multi-planetary systems to us — the star Gliese 876 with 4 confirmed exoplanets.
Today, 55 exoplanets are known to be potentially habitable.
Twenty of them are the size of Earth, one is the size of Mars, and the remaining 34 are super-Earths.
Kepler-452b is called "Earth 2.0" because of its supposed similarity to our planet. This object is located 1,400 light-years away from us.
When a distinguished but elderly scientist states that something is possible, he is almost certainly right. When he states that something is impossible, he is very probably wrong.
The only way of discovering the limits of the possible is to venture a little way past them into the impossible.
Any sufficiently advanced technology is indistinguishable from magic.
1. 2. 3.
The next step is to search for planets that are as similar to Earth as possible. Scientists are looking for them in the socalled “ Goldilocks zone ” or circumstellar habitable zone, the main feature of which is the possibility of finding water in the liquid phase. Astrophysicist WESLEY TRAUB , after analysing data from the Kepler mission (a telescope that specialises in searching for exoplanets and was in orbit from 2009 to 2013), came to an interesting conclusion: 20 %–40 % of “dwarf” stars similar to the Sun have exoplanets in the habitable zone! This means that the probability of the existence of a very close relative to the Earth is quite high, if not the existence of a “twin” of our planet itself. Whether there is life there and what level of development it has reached is another question. This makes it possible to give interstellar travel a practical dimension and start thinking about how to get there.
V₁ Speed of the spacecraft when entering the gravitational field of the planet
V₂ Speed of the spacecraft when exiting the gravitational field of the planet
U Speed of the planet Sphere of influence of the planet's gravity Resulting speed
Modern chemical engines have allowed humankind to overcome the transparent "armour" of the atmosphere. Voyager 1 was able to move away from Earth at a record distance of over 22 billion km (about 150 times the distance from Earth to the Sun), spending almost 43 years in space! This is impressive, but on the scale of the universe, such a distance is practically microscopic. The highest speed of the man-made mechanism, reaching about 17 km/s (relative to the Sun), is achieved largely due to clever gravitational manoeuvres and not the operation of the engine. For the same reason, the fastest spacecraft ever was the Parker Solar Probe, which on November 5, 2018, accelerated to a speed of more than 95 km/s when flying over the Sun and broke the record set by the similar Helios 2 probe — 70 km/s, set back in 1976. Parker, by the way, will retain this title until at least 2025, bringing the speed relative to the Sun to a fantastic 190 km/s.
Such speeds are made possible by the powerful attraction of the Sun and the giant planets used for gravitational manoeuvres . But isn’t it possible to achieve such speeds on our own? Unfortunately, no: modern chemical engines based on the exothermic reaction of fuel and an oxidiser compound cannot achieve this in principle. There is an insurmountable obstacle — the Tsiolkovsky rocket equation :
Initial mass of the aircraft *
Specific impulse of the rocket engine Final mass of the aircraft
According to this formula, the speed of a rocket can be increased in two ways. The first is to take as much fuel as possible, even at the ex pense of the payload. What happens in practice? For example, if the mass of a spacecraft is assumed to be 15 t, then to accelerate it to the speed of “Parker” (≈100 km/s), you would have to take all the oil reserves on the Earth (≈200 billion t) with you! In other words, there is no real engineer ing capability to achieve high speeds with single-stage rockets. In addition, the Tsiolkovsky equation does not take into account the need to overcome the Earth’s gravitational pull — it is at this stage that modern rockets spend the majority of their fuel.
Spacecraft are launched by mul tistage carriers, which on average ac count for 90 % of the total mass. Do not forget that the remaining 10 % in cludes not only the payload (satellite, manned ship, etc.), but also the struc ture of the craft itself — the hull, en gines, tanks, pipes, and hundreds of thousands of parts without which it cannot work. So, the astronauts have to endure severe weight limitations and take into account literally every gram to meet the carefully-calculated percentages of the payload.
But there is another variable in the Tsiolkovsky equation, the specific impulse , which can be considered with sufficient accuracy to be equal to the rate of expiration of the com bustion products! Maybe we should
The example of the Space Shuttle ships demonstrates that up to 95 % of the total mass is occupied by fuel installations. The rocket plane itself and its payload make up only 5 % of the total launch mass.
just find better fuel? But even here, hu manity has reached its limit. Currently, a “hydrogen-oxygen” pair is used, pro viding a speed of 4.5 km/s. The most common combination of “kerosene-ox ygen” is much “slower” — only 3.1 km/s, and the “methane-oxygen” combination, promising in terms of efficiency and energy intensity of the steam, can only offer up 3.5 km/s.
The main conclusion that follows from the Tsiolkovsky formula is that chemical rockets are unsuitable for serious travel in space . The fact that we continue to use them can be considered pure luck: if the mass of the Earth was just 40 % greater, then chemical rocket engines could under no circumstances take us to near-earth orbit, let alone on long-distance travel.
Now we’re in an interesting situation: we have engines with a huge thrust that can break the shackles of Earth’s gravity, but because of their small specific momentum, we are “locked” in our planetary system. Where is the answer? We will not consider the space warpers, compressors and staplers that turn the universe into origami — we’d rather leave such fantasy to science fiction writers. Let’s consider the problem of “getting from point A to point B, the distance between which is several light-years,” based on the modern technical capabilities of rocket science. The only way out of the chemical “dead end” will be fundamentally different engines with a much larger specific impulse, ideally close to the speed of light.
Looking ahead, we note that there are many projects working to construct such supermachines. There are also thermonuclear engines, theoretically capable of providing a specific impulse of up to 30,000 km/s. Its variation is the “interstellar ramjet engine ,” designed by physicist ROBERT BUSSARD, who proposed the collection of hydrogen and dust directly in space. Or we have the exploding rockets of the Polish mathematician STANISLAW ULAM , or photon annihilator ships that have already become a standard in science fiction. Also worth mentioning are the exotic solar and laser sails that symbolically take us back to the era of great geographical discoveries, and the amazing EmDrive by ROGER SCHEUER , nicknamed the “flying bucket.”
The EmDrive engine, according to its inventor, Roger Scheuer, allows you to convert radiation into thrust, which can help us reach the edge of the Solar System in a few months, not decades. However, not all engineers consider such an engine to be functional, since it violates one of the fundamental laws of physics — the law of conservation of momentum.
Unfortunately, none of these projects will be implemented in the near future. There are still fundamental, unresolved problems, the first of which is huge energy consumption. It is still unclear how to get so much energy. It is not yet even approximately clear how to carry out, for example, thermonuclear fusion or create antimatter on an industrial scale. But if work is still being done in these areas, there is not even a rough outline of a solution for the second problem. The fact is that it is not clear how to resist the huge strain of space.
What kind of strain are we talking about? Recall that space is not a vacuum at all. Interstellar space should be considered as an extremely rarefied gas with a concentration of one proton per cubic centimetre. Moving at sub-light speeds through this gas, a ship will experience a proton flux. Soviet cosmonaut and scientist KONSTANTIN FEOKTISTOV estimated its power at 100 kW per square meter, which is almost 100 times stronger than solar radiation — and this is only the influence of hydrogen! Now imagine what a speck of dust with a mass of only a milligram would do when flying relative towards a ship at a speed of 150 thousand kilometres per second (0.5 s)! Its kinetic energy would be approximately 11 GJ — this same amount of energy is released by an explosion of 2.5 t of TNT. Just one speck of dust what if it were a small rock? In that case, the fate of the ship is not so bright. These are just two of the myriad potential problems. Without addressing these fundamental issues, there is no point in taking on the rest.
It may seem that we are at an impasse, but the history of humankind is full of examples in which a solution was found to an impossible situation. All that’s left is to set such a goal for ourselves.
The first consumer device for energy produc tion, absolutely clean and safe, based on principles of low-temperature nuclear reac tions, will be released to the market. This means the end of the era of fuel extracted from minerals.
OYLA: There is no such device at the moment. It is still unclear how much time is left until the end of the fossil fuel era. Currently, 85 % of energy is generated from mineral extraction.
Internal combustion engines (ICE) in cars will be replaced with new devices for generating energy.
Generators powered by space en ergy will be developed. Power plants will begin to close; their time is up. Electrical networks will be dismantled.
OYLA: There are no such gener ators. We still generate power from power plants.
OYLA: Internal combustion engines are still used in 90 % of the world's cars. Interesting ly, the company Tesla, which produces electric cars, was created in 2003.
The first human clone will be created.
OYLA: Therapeutic cloning is being developed to produce stem cells, but human cloning is prohibited in many countries.
The world's last coal mine will shut down in India.
OYLA: In 2018, the last coal mine in Germany closed, but it is far from the last in the world. In 2019, the world produced about 8 billion t of coal.
NASA will create a new generation space telescope (the successor to Hubble).
OYLA: The James Webb Space Telescope was actually planned to be launched by 2007, but due to various problems it is expected to be launched in 2021.
All nuclear weapons will be destroyed.
OYLA: There are about 14,000 nuclear weap ons in the world. 2009
Construction of the Hilton Orbital Hotel will begin. Giant cargo bays of "shuttles" that previously fell to Earth and burned up in the at mosphere will be used as building materials.
OYLA: So far, the only place in space where a person can live is the International Space Station. But in 2021, the launch of the Au rora Station is planned — the first space hotel, which will begin to receive guests in 2022.
Technology for the transmutation of chemical elements will be devel oped, allowing us to control the structure of materials. Lead and copper, due to their greater utility than gold, will become twice as ex pensive as the "noblest metal.”
OYLA: There is no such technolo gy yet. Gold is still more expen sive than copper and lead.
Megawatt-hours will become the international unit of currency.
OYLA: There are about 180 different curren cies in the world.
A huge meteorite will fall on the cap of the North Pole. Serious damage will be caused to the coast of Greenland and Can ada. The "Spaceguard" project will be launched to identify and divert potentially dangerous comets and asteroids from Earth.
OYLA: In 2013, a meteorite fell near the city of Chelyabinsk (Russia). The damage was not catastrophic. There are various projects to detect space objects that are dangerous to the Earth, such as Pan-STARRS, ATLAS, NEAT, and others.
Artificial intelligence (AI) will reach the level of human intelligence. On Earth, two types of intelligence will coexist: bio logical and non-biological. Humanity will send spaceships with artificial intelligence to the nearest stars.
OYLA: It is too early to talk about the coex istence of two types of minds, although arti ficial intelligence is already used in scientific research, and it helps in the production of satellites, spacecraft, and processing photos from space.
In 1945, Clarke popularised the idea of creat ing global communication systems in the Wire less World magazine. He described a system of communication satellites in geostationary orbit, which today are sometimes called "Clarke orbits" in honour of the science fiction writer.
In the 1947 science fiction novel, Prelude to Space, Clarke suggested that in 31 years, a spacecraft capable of reaching the Moon would be created. "When the book was pub lished in 1951, I thought I was being fiendishly optimistic when I predicted the lunar landing in 1978," Clarke said. As you know, Neil Arm strong and Edwin "Buzz" Aldrin landed on the surface of the Moon for the first time in his tory in 1969. Clarke himself conducted live tele vision coverage of the expedition.
Clarke's thoughts on the prospects of communi cation in 1964 were as follows: "We could be in instant contact with each other, wherever we may be, where we can contact our friends any where on Earth, even if we don't know their ac tual physical location…It will be possible in that age, perhaps only 50 years from now, for a man to conduct his business from Tahiti or Bali just as well as he could from London."
In 1954, Clarke suggested that weather could be predicted using orbiting satellites. The scientific community supported his idea and subsequently, in addition to data from ground-based weather stations, began to turn to artificial Earth satellites for information.
"I am perfectly serious when I suggest that one day we may have brain surgeons in Edinburgh operating on patients in New Zealand," Clarke fantasised in 1964. So it happened. Robotic sur gery in the United States began to be practised in 2000. The da Vinci Surgical System is one such example.
The first human lands on Mars.
Infrared spectrum sig nals are received from the centre of the Milky Way galaxy. They clearly come from a technologi cally advanced civ ilisation, but all attempts to decipher them are in vain.
Dinosaurs are cloned from fragments of DNA. In Flori da (USA), Disney opens a theme park with dino saurs. Mini-raptors are beginning to replace guard dogs.
Neurological research leads to an understanding of the nature of feelings. Full immersion in virtual reality becomes pos sible.
Thanks to the “universal replicator,” you can recre ate any object, from fine dishes to dia monds. Agriculture and heavy industry be come obsolete, and the need for hard physi cal labour disappears. Art, education and entertain ment flourish.
Autonomous robotic colonies appear on the Moon.
Halley’s comet returns and humans land on its surface for the first time. Both dormant and active life forms are detected on the comet.
A “space drive” is invent ed that allows for reaching speeds close to the speed of light. Researchers are sent to neighbouring star systems.
Fully autonomous, self-sustainable mobile homes appear. For food synthesis, carbon is ex tracted from carbon di oxide.
Tired of living in an era that is too dull, millions of people decide to enter cryogenic sleep in order to “immigrate” to the future.
On October 4, 100 years will have passed since the first satellite was launched. The anni versary is celebrated not only on Earth but also on the Moon, Mars, Europa, Ganymede, and Titan.
An expected ice age does not occur due to global warming (the burning of fuel to replen ish carbon dioxide reserves has resumed).
The future is just beginning…
Today, more than 90 % of so-called general cargo (cargo of individual units transported in packaging) travels in containers. However, contrary to popular belief, these containers are not an American invention from the recent century. In the 1700s, efficiency-minded Englishmen started using big wooden boxes fixed on railcars to transport coal. Miners filled these boxes directly in the mine shafts, and then horses dragged the wagons to the pier on the Bridgewater
Already in the 18th century, the English used wooden boxes for transporting coal
Canal, which led to Manchester. On the pier, boxes with coal were loaded by crane onto barges and sent to the factories of the textile capital of England. Compared to the tedious bustle of sacks and carts, this innovation saved a lot of time, energy, and money. With the growth of railroad networks, the English method of transporting goods became widespread in a variety of countries. Towards the middle of the 19th century, iron containers made their appearance. After another half a century, we had closed containers designed for transportation on rapidly-developing automobiles. In the 1920s, the
Universal containers for storing and transporting cargo
Containers with a refrigeration unit for storing and transporting perishable cargo
Custommade containers for specific types of cargo
8 feet (2,600 mm)
20 feet (6,058 mm)
40 feet (12,192 mm)
45 feet (13,600 mm)
British came close to creating a unified container transportation system: the RCH standard , proposed by the logistics organisation Railway Clearing House. It united the motley railroad industry into a single transportation complex. RCH containers are 5- and 10-foot-long wooden boxes, which were primarily used on British roads, but, due to their fragility, did not gain the trust of maritime shippers.
On the deck of the world’s largest container ship, the OOCL Hong Kong , you can fit four football fields! Of course, the owner of this giant, the Chinese shipping company Orient Overseas Container Line, won’t allow any footballers to mess around on the deck. The container ship runs continuously between Shanghai and ports of Northern Europe — the British Felixstowe, Dutch Rotterdam, Polish Gdańsk, and German Wilhelmshaven. A full load is record-breaking: the ship can transport 21,413 standard 20-foot containers! Even imagining such a mass is frightening. If they were placed in a line end-to-end, they would stretch over 130 km.
In America, where the economy was booming at the end of World War I, the industry ignored the example of their English counterparts. Dozens of railroad companies introduced their own technical solutions that were rarely compatible with one another. Moreover, their reaction to attempts to streamline the disparate systems was far from welcoming. Any general national standard was out of the question. It reached a point when the goods travelling from New York to San Francisco were re-loaded several times — fiercely competitive railway operators preferred the
The giant flow of cargo crossing the oceans during World War II was being delivered in the tried and tested form of sacks, boxes, and crates. Just imagine hundreds of thousands of tonnes of goods that required not only the labour of thousands upon thousands of dockworkers but also an uncountable number of hours for loading and unloading! However, this does not imply that the army engineers were sitting back with their arms crossed. They were working on the development of container transport systems, but their introduction and testing were constantly delayed due to various constraints.
Until McLean’s invention, cargo was transported in sacks with the help of a cargo net
operation of their own fleet of locomotives and wagons within their transportation zones.
For instance, the Chicago North Shore and Milwaukee Railway companies transported car and ship engines in standard metallic containers. Towards the beginning of the 1940s, containers were widely used; the method of transportation of cargo in closed containers installed on open railroad platforms received the name “piggybacking.” The idea of globalising the containers lingered in the air. Just a few more steps were left.
In 1942, in the Imperial Ministry of Railways of Germany, the Eisenbahn Behälter was born, a steel container that can accommodate approximately 20 t of general cargo. It was designed for any mode of transportation (except aviation and cart-drawn systems).
Only in 1948 did the U.S. Army Transportation Corps present Transporter , a metal container with a capacity of 4 t. Its basis was a 2.6 × 1.9 × 2.1 m welded frame, sheathed with a corrugated steel sheet. It featured a double-leaf door built into the front wall and slinging rings welded to the upper corners of the bearing frame. Transporter became the core component of US Army logistics during the Korean War, and later, the basis for the standard Container Express (CONEX), which was adopted in 1952. By the mid-1960s, the US Army had a fleet of 100,000 containers, partially taking over the supply of American units in Vietnam.
Why only partially? Because MalCOlM MCLean , “the father of containerisation,” who compacted the delivery of general cargo into a single complex, entered the game. According to one version, large losses forced McLean to think about bottlenecks in logistics. His trucks idled in port, waiting for goods, and of course a ship, plane, train, or truck only brings in a profit when it is carrying a load. In those years, transport ships spent half of the time at sea and the other half in ports loading and unloading. Therefore, if you see rows of inactive liners, you can deduce that something isn’t right. Planes should be flying, and not sitting on the concrete.
Having arrived at the pier, enraged McLean saw a team of not-so-agile dock workers unloading sacks from the hold. First, the workers laid a couple of dozen sacks in a cargo net, lifted it with a crane, and once on the dock, loaded the bags onto a truck for a total price of $6 (about $60 in today’s dollars) per tonne. Here, the businessman was struck by an interesting, though not original, idea. To speed up the loading and unloading process, one needed to work with larger objects. Further development of this thought led to a logistical revolution — to enhance efficiency, these large objects needed to be transferred from door to door with minimal adjustment. With time, a special term was coined for this approach, intermodality.
Intermodality (from Lat. modus , meaning “between ”) is the seamless use of various types of transport in one transport system.
Why would the owner of a successful company like McLean Trucking, with a fleet ranked fifth largest in the nation, need to improve? One would think that 32 massive terminals, located across the entire country and serving almost 2,000 heavy-duty trucks would work well enough!
The answer, of course, lies in profits, as well as the federal structure of the US. Every state has its own established fees and taxes. Sometimes the border between states needed to be crossed just like an international one, with customs control and payment of fees.
McLean was forced to think about optimising the delivery costs of goods, for example, from New York to Florida. If transported by truck, they cross at least five states, each with their own regulations. Transport via railroad would mean using the services of sworn competitors like the New York Central Railroad and Atlantic Coast Line Railroad. This would again involve expenses and delays! Could
Keith Tantlinger, the engineer who revolutionised container design
containers cross the seas every second.
Twistlock technology, invented by Tatlinger, are still used to this day
this problem be solved radically, rejecting ground modes of transportation alto gether?
No sooner said than done! Malcolm McLean became a shipowner. And since the law prohibited land transport com panies from venturing into sea transport, McLean found a loophole. He formal ly left the auto-transport business and, having sold his portion of McLean Truck ing, bought a shipping company and two T2 series army tankers, which were mass-produced during the war. The ves sel Potrero Hills , with a displacement of 16,5000 t, was renamed the SS Ideal X and became the world’s first commercial container ship.
Now it was time to deal with the containers.
For this, McLean recruited the engineer and mechanic Keith Tantlinger , Vice President of Engineering at Fruehauf Trailer Corporation, from whom McLean had contracted for the refurbishment of his trucks. It should be said that Tat linger had already worked on some pilot projects that were highly acclaimed by his new boss. His main innovation was a sturdy frame with strengthened corner posts, welded from steel channel bars. This allowed the containers to be stacked in several tiers without fearing that frag ile lower crates would be crushed by the ones above. To prevent the stacks from falling apart, Tatlinger developed a mounting system of corner fittings with locks, “Twistlock.”
The walls and roof of a contain er were covered with corrugated steel sheets 1.5–2mm in thickness, but the bottom required special preparation, as it needed to support a significant weight. To do so, additional steel beams were welded in the lower plane of the bearing channel to form a strong lat tice. A steel sheet was placed on top and packed down by pressed plywood with a thickness of up to 40 mm. A double-door through which the container would be loaded was hinged at one end of the resulting box.
All of these specifics line up with the characteristics of modern containers, right? Yes, except for the unusual length of 35 feet (a little more than 10 m). This
is due to the fact that the standard plat form-trolley of common freight trucks such as White Freightliner, Kenworth Cabover, or International Emeryville had a length of no more than 40 feet (12 m).
So, on April 26th, 1956, the former tanker and now container ship, SS Ideal X, loaded 58 new trailer vans (they later came to be called containers) and sailed out of Port Newark-Elizabeth, New Jersey, having set course for Houston, Texas. The shrewdest guest invited to the ceremony
Upper cross beamSealing rubber Container number Corner fitting
Container doors
Material label (shows what the container is made of)
CFC faceplate (indicates admit tance into service)
Handles
Lower cross beam
Locking mecha nism rod
Corner fitting
Corrugated side wall
Container size and type code (indicates length, width, and height of the container)
Container characteristics (capacity, weight, volume) Door hinge Slots for forklift
Loading of the containers on the ship SS Ideal Xwas a top offi cial of the International Longshoremen’s Association, FreDDie FielDS . As the story goes, when asked what he thought of the ship, he answered, “I’d like to sink that son of a gun!” Only Freddie’s choice of words was a bit more colourful.
As if he had foreseen it, the cost of shipping tons of cargo diminished by over 30 times thanks to containers. Loading times decreased sixfold, and the number of necessary personnel shrunk by four. The war in Vietnam helped McLean to persuade the last remaining sceptics. Demonstrating truly fiendish resourcefulness, the businessman went to the Army leadership and offered to organise the delivery of cargo supplies through his company, pledging to deliver containers not just to the ports of Vietnam, but also to the units’ deployment sites. The engineering corps, which was building landing trips and roads, became McLean’s
Homes built from containers are actually quite comfortable to live in
first client. They received 226 containers with explosives onboard (but without detonators, so they were practically safe). Logistic analysis showed that the transportation cycle decreased by five times, and the productivity of dock workers increased by six. Is there anything left to prove?
Much time has passed since then. Containers have become an integral part of global transportation, making up three-quarters of the total world cargo turnover. Every second, there are about 4,000 vessels at sea carrying 20,000,000 containers. As MarK LeVinSOn noted, “containers have made the world smaller but the world economy bigger. ” The “box” is so convenient that containers have even broken into industries that are not at all connected to transport. For example, power stations, boiler rooms, data centres, cryptocurrency mining farms, retail outlets, and missile complexes. Their fi nal advantage is that they are fairly comfortable to live in. Maybe future lunar and martian stations will also be assembled from containers?
— this is the total cost reduction of transferring 1 t of cargo after the container revolution.
Mining farm Power station Rocket complexYou could see chaotic scenes in the 19th century, such as this illustration of a game between England and Scotland played at the Kennington Oval, the same field that hosted the first FA Cup final in 1872
We do not know exactly when football madness first began. Kicking a ball around was popular from Egypt to South America, from Greece to China. But the word “football” first appeared in a proclamation issued by K E III of England in 1363. The instigator of the Hundred Years War forbade his subjects from playing “handball, football, or hockey; coursing and cock-fighting, or such idle games.”
In those days, the inhabitants of the British Isles played football in a crowd, without any rules or restrictions on the number of players. The games would often end in street fights, with ensuing consequences. But despite bans from city authorities, football continued to gain popularity.
You don’t need much to play the most popular game on the planet: a lawn, a ball, and a few friends. In turn, it will give you an emotional charge and sense of team spirit
England v Scotland, 1905 illustration of international football at Crystal Palace with Scotland in striped jerseys
The modern format of the game, in which two teams of 11 play on a limited field, appeared only in England in the middle of the 19th century. But every football team played by their own rules. That was a problem for tournaments. A single code, “The Cambridge Rules ,” appeared in 1846, turning street entertainment into a serious sport.
Many features of the modern game appeared thanks to the British: the referee’s whistle (before that, a clap of hands or a bell were used to signal to players), the referees themselves (in the beginning, controversies were resolved by team captains), the goal net, and much more.
Football spread throughout the world like an epidemic. Travellers, sailors, soldiers, merchants, and missionaries took the game with them on their journeys. With its rapid growth in popularity, football organisations also developed. In May of 1904, the International Federation of Association Football (FIFA) began its work. It was established by representatives of France, Belgium, Denmark, the Netherlands, Spain, Sweden, and Switzerland. Today, FIFA includes more than 200 national federations.
Since the 1960s, leather balls have been replaced by synthetic ones. It was around that time when the “Buckminster Ball” or, simply, “Buckyball” came onto the scene. Even those who know little about football will recognise it — a sphere consisting of black pentagons and white hexagons. In 1970, a similar ball consisting of 12 black pentagons and 20 white hexagons, Telstar, became the o cial ball of the World Cup in Mexico. The tournament was the first to be broadcast live, and the design of the ball was perfect for the black and white television of that time. Its “relative,” Telstar 18, was the main star of the World Cup held in Russia in 2018.
so intense that the victories of your favourite team turn into a holiday — and its defeats can move even the most stoic of fans to tears. For many, football is not just a game. It’s a way of life.
stoic to
Every four years, the World Cup is played with a new ball. Football technology has come a long way since the 1930s. The very first World Cup used balls made in England. The “T-Model” ball got its name from the distinctive t-shaped panel on its sides. Since then, the materials and the aerodynamic characteristics of the ball have undergone great changes. Modern balls have a perfectly flat surface and are made completely of synthetic materials.
A football match consists of two halves of 45 minutes each. In some cases, additional time may be given — for example, if it’s a knockout stage match and the winner is not determined (a draw).
At the beginning of the match, the ball is set to the centre circle . Then, the referee tosses a coin to determine which team can kick-o the ball and start the game. The opening team is called the attacking team . Their rivals, the defending team , will open the next half. The ball is considered to be entered into the game when it crosses over into the opponent’s half. Now, the task of each team is simple: score as many goals as they can and try not to let any into their own goal.
Players make passes to each other. If they are accurate, the attack goes on. If the ball does not roll over the lawn but flies through the air, then it’s a high ball cross , an aerial pass . If the ball has left the pitch and crossed the sideline after contact with a player, it’s out . The ball will be thrown in by a player of the opposite team. When the ball goes out of play crossing the goal line, there will be a corner kick or a goal kick. If the last players touching the ball were the players of the attacking team, then the goalkeeper
will execute a goal kick from the boundary of the goal area. When the ball has left the field because of the defending team, the opponents are entitled to a corner kick . In this case, the ball will be placed in a small arc area in the corner of the field of play. From there, the player either crosses a high ball into the penalty area or passes the ball to a teammate.
Players can and must contest the other team’s players trying to take possession of the ball, but on one condition: they do not harm the player with the ball (the one who is being tackled). The referee will readily punish the o ender, which may involve a penalty card and a free kick .
There are free kicks and direct free kicks. If the players violate the rules, the
referee may indicate for a free kick or a direct free kick to be taken. A direct free kick means that the player who executes it can either try to score the goal directly or pass the ball to a partner. A simple free kick does not allow for aiming at the goal directly. We can know whether we are dealing with a free kick if the referee keeps a raised hand while the kick is being executed.
When a direct free kick is indicated, the field players help the goalkeeper by making a wall in which they stand shoulder to shoulder, 9 m from the ball (the referee controls the distance, although players always try to outsmart him and get a little closer to the ball). Building a proper wall is up to the goalkeeper. Often the performer of the direct kick hits the wall; not everyone is able to deftly bend the ball around it. Or the players jump out to defend with a header, not allowing the ball to reach the goal.
The game involves two teams. Each must have 11 players, including one goalkeeper. Everything that happens on the football field is subject to certain rules, and each player has a role and tasks.
Their task is to prevent the ball from getting behind the goal-line; in other words, to defend the goal. This is the only team player who is allowed to handle the ball. However, they can do so only in their own penalty area marked with a white rectangle next to the goal. There is a smaller rectangle inside that area, the goalkeeper’s area. No one has the right even to touch the goalkeeper there. Therefore, their uniform is di erent from the basic jersey of the team, which makes them more easily recognisable to the referee.
Typically, there are four or five of them. They have to keep up everywhere: helping the defenders and joining in on attacks. They often score goals.
You can’t win a match without scoring a single goal. This is the main task of the attackers. There are usually one or two in play. These players come in all sizes: they can be small, brisk, fast forwards, or powerful and tall, using their heads to strike. The main thing is to be able to outsmart and outperform the rivals to score a goal.
NICKNAME: Black Panther
COUNTRY: USSR
CLUB: Dynamo Moscow
STATS: Conceded only 70 goals in 74 international matches.
Yashin was the best goalkeeper of the 20th century, according to FIFA, IFFHS, World Soccer, France Football and Placar. He is the only goalkeeper in history to be awarded the Ballon d’Or (“Golden Ball”) by France Football. Based on FIFA’s data, he deflected more than 150 penalty shots, surpassing all other goalkeepers in the history of professional football.
Unlike the goalkeeper, a defender plays strictly without their hands, and there are a lot of them on the field — three or four depending on the tactic chosen by the trainer. If they decide to play deep defence, then there will be five of them on the field. In modern football, defenders are mostly tall folks: it’s much easier to head the ball if you’re already pretty high o the ground. However, there are also “jumpy” players who are capable of gaining possession of a ball even if the defender is a head taller than them. These players do not
NICKNAME: Zizou
COUNTRY: France
CLUBS: Cannes, Bordeaux, Juventus, Real Madrid
STATS: Scored 128 goals in 681 matches
Zidane is recognised as both one of the greatest players in the history of football and as a talented coach. He has placed as one of the FIFA World Players of the Year six times, taking first place in 1998, 2000, and 2003.
They control the course of the football match. The referee ensures that all players comply with the rules, imposes disciplinary action, takes the teams out on the field and leads them back to the locker rooms, monitors time,
often manage to score, but their mistakes may well result in a missed goal.
NICKNAME: Der Kaiser (The Emperor)
COUNTRY: Germany
CLUBS: Bayern Munich, New York Cosmos, Hamburger SV
STATS: Scored 94 goals in 709 matches
Beckenbauer is considered to be the football player who invented the role of the libero — free defender. He is one of only two people (along with the Brazilian Mário Zagallo) who has won the World Cup both as a team captain and as a coach.
NICKNAME: El Pibe de Oro (The Golden Boy)
COUNTRY: Argentina
CLUBS: Argentinos Juniors, Boca Juniors, Barcelona, Napoli, Sevilla, Newell’s Old Boys.
STATS: Scored 258 goals in 492 matches
Maradona is one of the greatest strikers of the 20th century. He scored the “Goal of the Century” in the England v Argentina match at the 1986 World Cup.
and records important details of the match. As a rule, there’s one referee out on the pitch and two assistant referees on the sidelines. It is strictly forbidden to argue with the referee: you risk not only receiving a verbal warning, but also a yellow or even red card.
Being o side, or “out of play,” is the situation in which, at the moment of passing the ball, the player of the attacking team is closer to the goalkeeper than the last player of the defending team. That is, there is no player from the defending team between them and the goalkeeper. In this situation, the player has no right to continue the game, hence the name “out of play.” A goal scored from the o side position will not be counted. Between the attacking player and the goal, there must be at least two people from the opposing team, that is, the goalkeeper and a field player. To avoid being called o side, a player must ensure that there is at least one defender between the teammate to whom they are passing and the goalkeeper.
Why do we need an o side rule? Before the start of the game, both teams are on equal footing. But when the ball is in play, the advantage passes to the side of the attacking team. All that remains for the defending team is to try and tackle the ball. But it’s an almost impossible task, as it moves more quickly than a running player, so the attacking team could easily score a goal. The o side rule was introduced to balance attack and defence in the game. In short, o side is the line that passes through the last player of the defending team. The team decides where to draw it. Without o side players, to score, you would simply have to stand and wait for the ball to be passed to you.
O sides often cause heated controversy, especially when it comes to deciding goals. The decision on the o side position is made by the chief referee with the help of the assistant referees. If the linesman notices an o side, they should
FIFA World Cup Germany 2006, Italy-France final, Olympiastadion: referee H E gives a red card to Z. Z and expels him for a foul against M. M
immediately lift the flag and keep it horizontally in front of them. This signals to the chief referee: there was play o side. It is usually easier to detect from the position of a linesman, but the referee has the right to disagree with their colleague’s decision.
Emotions on the field often run high. When this happens, players can be given a yellow card . If you receive two in one game, you will be removed from the field and leave your team with fewer players. What are the reasons for yellow cards? They are used as punishment for deliberate handballs, stalling (usu ally
The football field must be level, with no foreign objects on it. The best option is a grass field. The quality of the game depends on the lawn. It is typically cut by lawnmowers in di erent directions, so it seems that the field is divided into strips. They become “additional markup” and help the referees to assess the situation better, identify o sides, and position walls for direct free kicks. Grass height should not be more than 3.5 cm, according to FIFA regulation. Before the match starts, the referee checks the suitability of the field, equipment, and markings.
by goalkeepers in the last minutes of the match, when their teams need to maintain the score), rough play, unsportsmanlike conduct, disputes with the referee, simulation (feigning injury), leaving or entering the match without the permission of the referee, and a few other violations.
Two yellow cards add up to a red one, which is equivalent to a ban from the field. You can get a red card straight away for rough play — an insult, kicking an opponent, or tackling from behind.
Of course, all the cards are shown at the sole discretion of the referee, and the same situation may be construed di erently by various referees. Football players almost always push back against an unwanted decision and swear: “Ref, it’s not my fault !” But it doesn’t change a thing.
The idea for red and yellow cards can be traced back to one particular referee, K A . They appeared after the quarterfinals of the World Cup in 1966, when in the match between Argentina and England, Argentinean player A R took down his opponent in a tackle. The chief referee of that match was the German R K , who couldn’t speak English or Spanish. It took him a long time to explain to the violator that the rules stated he must leave the field. Ken Aston saved the day by explaining everything in English. It was then that o cials began to think about a form of universal communication that all referees and players would understand. The cards appeared at the 1970 World Championships in Mexico. The first yellow card was shown to the Soviet-Georgian player K A during the match between Mexico and the USSR.
As you’ll recall, the goalkeeper can handle the ball only in their own zone, which is called the penalty area. For any violation of the rules on the part of the defending team, there is a penalty — a direct free kick from a distance of 11 m. There is no one but the goalkeeper of the opposing team between the striker and the goal. The goalkeeper stands on the goal line, and the remaining players are outside the penalty area. At such a short distance, the goalkeeper simply does not have time to assess in which direction the ball will fly. More often than not, a penalty is considered an excellent opportunity to score a goal, so the players try their hardest not to violate the rules in their penalty area.
A post-match penalty shootout is an ordeal for the nerves, both for the players and their fans. It is possible in the playo stage at the World or European championships when a draw is not an option, and 90 minutes of regular time and two extra halves of 15 minutes have not revealed a winner. The teams shoot five penalties each, and if even this does not determine who is victorious, then the shootout continues.
The “Doomsday Clock” is a symbolic clock that displays the countdown to a global catastrophe (the closer to midnight, the greater the danger). In January 2020, the hands of the clock came the closest to midnight they have ever been — only 100 seconds away. The clock now reads 23:58:20, indicating that calamity is close at hand. For reference, when the USSR tested the first hydrogen bomb in 1953, the hands of the clock were still two minutes from midnight.
The history of humankind’s origin and development covers about 70,000 years, but only the last five centuries have been marked by the rapid and phenomenal growth of our power. One of the most serious mysteries unravelled by science over those five centuries is the energy contained in the atomic nucleus.
In 1939, German physicists O H, F S , and Austrian physicist L M experimentally confirmed the splitting of an irradiated uranium nucleus — the heaviest element existing in nature. A year later, Soviet physicists G F and K P discovered spontaneous fission of uranium-238. Around the same time in France, physicist F J-C and his colleagues received five patents for the creation of a nuclear reactor. In the US, the Advisory Committee on Uranium was organised in 1939, and in 1943 the Manhattan Project began its work to create a nuclear superweapon. By July 1945, the United States was conducting the Trinity atomic bomb tests at the Alamogordo test range.
Less than a month later, on August 6 and 9 respectively, the US bombs “Little Boy” and “Fat Man” were deployed against the civilian residents of the Japanese cities Hiroshima and Nagasaki. To date, these are the only two instances of nuclear bombing in history. Thus, the end of World War II brought not only victory over fascism but also a new set of crises. When conventional weapons were no longer su cient to keep the enemy under control, nuclear weapons of unprecedented power found their way into the hands of people.
These catastrophes were the first step towards the creation of a disarmament movement. To draw the attention of political leaders—and, indeed, of all humankind—to the problem of nuclear weapons, as well as to dwell on the consequences of their use, a group of scientists from the University of Chicago started a column in the Bulletin of the Atomic Scientists called the “Doomsday Clock.”
In 2020, the hands of the Doomsday Clock were moved forward by 20 seconds to 23:58:20. The decision of the Bulletin of the Atomic Scientists cited climate change denial, the US withdrawal from the Iran Nuclear Deal, and the spread of cyber-based disinformation as justification for the clock’s recalibration (their press release was written before the start of the global COVID-19 pandemic).
The idea of a symbolic clock that counts down the seconds to total disaster can be credited to the American artist M L, who was asked by one of the editors of The Bulletin to design a cover for their issue. First, Langsdorf planned to use the symbol for uranium, but after seeing that scientists were deeply concerned about the rapid development of nuclear physics, she came up with the clock instead.
The hands of the clock on the cover displayed 23:53 , but the position of the minute hand, according to the artist, did not carry any significant meaning. She just thought that the positioning “looked good.” The idea appealed to the editorial board because it accurately expressed the overarching idea: humankind doesn’t have much time left to get nuclear weapons under control.
The scientist E R , a Russian-born American biophysicist, especially liked the idea of clocks. Being an active supporter of disarmament, he began to slowly move the hands of the clock forward so that they reflected the imminence of a nuclear catastrophe or, conversely, our distance from one. He then explained his reasoning for the shifting time on the pages of The Bulletin After Rabinowitch’s death in 1973, the decision to move the minute hand (or to leave it be) has been made every year at the meeting of The Bulletin’s advisory board, which at di erent points in time included Nobel laureates and other world-renowned scientists. Since its appearance in 1947, the clock with its shifting hand has appeared on the cover of The Bulletin 25 times.
Analysts decided to move the clock’s hand for the first time in 1949, when the USSR conducted their first nuclear weapons testing, ending the US monopoly on nuclear weapons. The clock read 23:57 . The Bulletin put it this way: “We do not advise Americans that doomsday is near and that they can expect atomic bombs to start falling on their heads a month or a year from now; but we think they have reason to be deeply alarmed and to be prepared for grave decisions.”
The heavy metal band Iron Maiden has a single called “2 Minutes to Midnight.” It refers to the events of 1953 when the clock was set to 23:58 and the minute hand was the closest it would ever come to midnight — until 2020, of course.
Although the global situation was growing ever more perilous, and the aggravated tensions between the US and the USSR marked the beginning of the Cold War, the hands of the Doomsday Clock did not budge again until 1953. The shift by one minute to 23:58 was instigated by the appearance of a new weapon—the hydrogen bomb—on both sides of the conflict. In the West, the Soviet project was known as “Joe 4,” after the US media’s nickname for Joseph Stalin (“Uncle Joe”). “Only a few more swings of the pendulum, and, from Moscow to Chicago, atomic explosions will strike midnight for Western civilisation,” wrote The Bulletin .
Then came the “thaw” — the mortal enemies realised the danger that nuclear weapons posed to civilisation, and they made the first attempts at negotiations. Additionally, the scientific community became more active, establishing the Pugwash Conferences on Science and World A airs in 1957, which advocated for disarmament and international security. All this led to the hands of the clock being turned back for the first time in 1960, and midnight was now all of seven minutes away. The time was now 23:53
The hands of the clock remained fixed even at the peak of the Cold War, during the Cuban Missile Crisis in October 1962. For two weeks, relations between the USSR and the United States were very, very tense. To put it simply, the world was on the brink of a nuclear war, the instigating act being the US deployments of nuclear weapons to Italy and Turkey and the failed Bay of Pigs operation in 1961, to which the Soviet Union responded by transferring nuclear missiles to the territory of their ally, Cuba. Analysts did not consider it necessary to change the position of the hand because the public at that time knew very little about this very short, albeit tense, stage.
A year later, on August 5, 1963, the United Kingdom, the United States, and the USSR signed a treaty limiting the testing of nuclear weapons. The atomic scientists greatly appreciated this step and gave humanity another five minutes — 23:48 .
However, these five minutes were soon lost in 1968, when new major players entered the nuclear arena: France and China. The situation was complicated by regional wars: the US deployed troops to Vietnam; Pakistan and India fought over the disputed territories of Jammu and Kashmir; in the Middle East, the Arab-Israeli conflict flared up, then faded, but never completely ended. Fearing international anarchy, for the very first time The Bulletin changed the position of the clock in response to non-nuclear threats.
Escalation of the Soviet war in Afghanistan 1988
US launches the Strategic Defense
Initiative, nicknamed the
first nuclear bomb
USandUSSRratifythe Intermediate-RangeNuclear ForcesTreaty 1953 1980
Continued developmentof nuclear
programsin North KoreaandIran Anti-BallisticUSwithdrawalfromthe MissileTreaty
climate change continues
“DoomsdayInceptionofthe Clock” inEscalationofthewar Vietnam AggravationofUS-USSRrelationsoverthe SovietinvasionofAfghanistan“SmilingTestingoftheIndiannuclearbomb Buddha” FirsttestingofnuclearweaponsinPakistan TreatyTheUSratifiesthe liferationontheNon-ProofNuclear Weapons BerlinFallofthe Wall 1949
USSR test their
US and Russia modernise their nuclear arsenals Lackof action on
of climate change
US and USSR test thermonuclear bombs
systemsUSrefusaltodeploymissiledefence inEasternEurope weaponsBanontestingnuclear intheUSand USSR #1 DECEMBER 2020 83
1972
StrategicArmsLimitaratifiedtionTalksAgreement between the US and USSR
“Star Wars program”” 1991
denial, and propagation of disinformation Statement by US president Donald Trump on nuclear weapons and denial
weapons testing Continued nuclear crisis, climate change
North Korea continues nuclear
The UN Treaty on the Non-Proliferation of Nuclear Weapons in 1969 put the clock at an encouraging ten minutes before midnight. Only Israel, India, and Pakistan refused to ratify the agreement. Two more minutes were added in 1972 for the signing of the USSR and US treaty SALT-1, which limited strategic weapons.
Against the backdrop of the relative pacification of the globe’s main rivals, the USSR and the United States, nuclear tensions increased between China and India. China had become a nuclear power in the 1960s, and India’s confrontation with Pakistan continued. On May 18, 1974, India secretly tested its first nuclear bomb, “Smiling Buddha.” The time on the clock changed — 23:51 .
In the early 1980s, the time on the Doomsday Clock again reached no less than seven minutes to midnight, but the situation was still turbulent. The process of disarmament stalled, and the first major terrorist attacks took place in the world: in Bologna, Italy, and during the Oktoberfest in Germany. After the failure of the SALT treaties between the US and USSR, The Bulletin called them “nucleo-holics—drunks who continue to insist that the drink being consumed is positively ‘the last one,’ but who can always find a good excuse for ‘just one more round.’”
The hand of the clock crept closer to midnight. In 1984, scientists left only three merciful minutes as a plea to the world to think again. Of concern were the open anti-communist policies of the US president Ronald Reagan. In 1984, as he was checking the microphone before a scheduled radio address to the nation, he decided to joke and changed the text of his speech: “My fellow Americans, I’m pleased to tell you today that I’ve signed legislation that will outlaw Russia forever. We begin bombing in five minutes.”
Hope for the reversal of time appeared only after the fall of the Berlin Wall (again 10 minutes remained until midnight), and then the complete end of the Cold War, which added a whole 7 minutes — 23:43 . Seventeen minutes until nuclear midnight is the longest window of time allocated to humanity in the history of the clock. However, despite the destruction of significant stocks of nuclear weapons, about 40,000 were still scattered around the globe after the dissolution of the USSR. In 1998, India and Pakistan displayed their nuclear bombs. Judgment Day was approaching — 23:51 .
The Doomsday Clock has gradually become a symbol of not only impending nuclear catastrophe but also of the apocalypse in general, the reasons for which are broad: wars of conventional weapons, terrorism, overpopulation, and political strife, among others. In 2007, The Bulletin analysts compared the threat of climate change to that of nuclear warfare. “Global warming poses a dire threat to human civilisation that is second only to nuclear
weapons,” they wrote in 2007, once again shifting the hand towards midnight — 23:55
In the opinion of atomic scientists, there has been no real progress toward solving environmental problems. The year 2012 brought stagnation not only in ecological processes but also political. Five years passed, and the clock on The Bulletin’s cover seemed frozen in time. Military conflicts in Ukraine and Syria added to the di culties. In 2015, allocating only three minutes to midnight, the scientists issued a verdict: “These failures of political leadership endanger every person on Earth.”
What about today? Three years ago, when the clock celebrated its 70th anniversary, for the first time in history the hand was moved not by minutes but by seconds — 23:57:30 . “It is two and a half minutes to midnight, the Clock is ticking, global danger looms,” The Bulletin wrote.
Donald Trump’s presidential victory in the US and continued tension with North Korea gave new occasion for a nuclear scare and the movement of the clock’s hand. On January 25, 2018, the clock again found itself set to 23:58 , as it was in 1953. Meanwhile, the situation has only worsened, with The Bulletin’s experts deciding to move the clock forward to only 100 seconds to midnight — 23:58:20 . According to the atomic scientists, humanity is as close as it has ever been to global catastrophe. Despite this, The Bulletin leaves room for hope, writing, “But just as humanity has come perilously close to obliterating itself, it has also experienced moments of exquisite forethought, well-planned e orts to protect the planet accomplished by determined people.” It seems that the future can still be corrected but only through global e orts of tremendous proportions.
Despite the depressing forecast and the unstoppable hand of the Doomsday Clock, it is still possible to reduce the level of danger. The fact is that our future doesn’t only rely on scientists or world leaders but on you and me as well.
By showing more interest in the topics of nuclear disarmament and climate change, everyday citizens can protect our way of life and the well-being of our planet. Although nuclear weapons and global warming (at least for the time being) fall outside the realm of our typical daily concerns, the more we discuss these issues with friends and loved ones, the more confidently we will be able to defend our interests before politicians. The Bulletin’s analysts believe that leaders react to the appeals of their constituents, who can use the power of the Internet to ensure there is a peaceful world waiting for our children and grandchildren. Together, we must demand action to reduce the threat of nuclear war and climate change. The fate of our planet depends on it.
The time 23:43, 17 minutes to midnight, is the biggest window displayed since the creation of the clock. This occurred in 1991 in response to the end of the Cold War.
The first musical reference to the Doomsday Clock was in the song “7 Minutes to Midnight,” written by Pete Wylie in September 1980
In season ten, episode seven of the British sci-fi television series Doctor Who , “The Pyramid at the End of the World,” the story of a 5,000-year-old pyramid is told. Due to interference from the monks who occupy the pyramid, all the clocks in the world begin to display a countdown to midnight in the style of the Doomsday Clock.
In 1984, the Australian rock band Midnight Oil released their song “Minutes to Midnight”. The album cover depicted the city of Sydney after a nuclear explosion. Later, group leader Peter Garrett was elected to parliament as a representative of the Nuclear Disarmament Party before being appointed Minister for the Environment.
The clock has an o cial Twitter account, @BulletinAtomic, where the new time is reported and you can find links to materials about nuclear weapons
Whenever something happens in the world, there is always someone to blame. And if this “something” is on a global scale, then it obviously didn’t happen without some kind of conspiracy! Are doctors advising you to get vaccinated? They want to cash in on vaccine sales, of course! Man walked on the Moon? It was a hoax! And worldwide surveillance? We are all in danger... until we turn on our common sense and start to think critically.
There are several conspiracy theories that state that some secret society governs the world. For example, the Illuminati the original name given to various occultist, philosophical associations—were, as a rule, in opposition to the authorities. But today, conspiracy experts say this is a small group composed of the wealthiest people in the world who have leverage over global leaders and control the activities of many, if not all, countries.
It’s necessary, however, to understand that secret world domination would require colossal resources, well-established infrastructure, and top specialists in every field. Meanwhile, every participant would have to be incredibly devoted to their work in order to keep silent about their secret mission, and they must not even consider betrayal. But, in addition to the inner circle of main villains, a huge workforce would be needed to handle documents, conduct espionage, configure servers, repair printers, and even just clean up the o ce after it’s all done! The leaders would have to be nothing short of management geniuses to keep such an organisation running smoothly. All of this means that the selection and training of personnel in the Illuminati would have to be organised with no lower standards than an intelligence service. Any error would threaten their secrecy.
Some will object, saying that conspiracies still happen in real life. And they are right. For example, consider the many coup d’états throughout history. The di erence here, though, is obvious. Coups are organised by small groups of like-minded people who pursue a specific goal and disintegrate after it is achieved (or, well, after the conspiracy is uncovered with all the ensuing consequences).
The Manhattan Project was far more massive in scale: over 120,000
The Manhattan Project was a secret US program supported by Canada and the United Kingdom to develop a nuclear weapon during World War II. Many outstanding scientists were among the participants of the project: E F , N B, J V N , and R F .
In the period from 1942 to 1945, three atomic bombs were created: the first was detonated at a test range in the state of New Mexico, and the other two were dropped at Hiroshima and Nagasaki. The high level of secrecy was due to a desire to conceal the development of nuclear weapons from the Axis Powers and the Soviet Union.
people worked to implement it. But builders, cooks, and even many of the scientists did know the main goal of their project. They were informed only of its importance and the need for secrecy, and they were told to perform specific tasks. Each employee underwent strict FBI scrutiny, incoming and outgoing mail was censored, and all people involved signed a non-disclosure agreement. Despite all the precautions and generous funding, the system did not work perfectly. For example, R F described some of the work of the Los Alamos Laboratory in his book, Surely You’re Joking, Mr Feynman! When trying to outwit the security, he found a hole in the fence of the top-secret enterprise, which lazy workers had not investigated, and easily picked the locks of storage containing classifi ed documents. The o cial report of the US Department of Energy refers to 1,500 cases of unintentional information leakage and 1,200 cases of rule violations pertaining to the handling of classified documents.
What will the conspirators receive?
Is it worth the e ort?
What makes people keep “corporate” secrets for decades?
The life of conspirators is complex, involves risk and deprivation, and requires constant self-control. The bearers of secret knowledge cannot boast about their accomplishments at parties or tell their families about how their day at work was. What motivation and benefits would cause a person to go to these lengths?
Already 50 years have passed since the first landing on the Moon , but, so far, none of those involved in the “conspiracy” have blabbed about it. Of course, astronauts and project managers have received honour and fame for this “deception,” so they have had a reason to remain silent for so many years: their reputation is at stake. But ordinary engineers would have had motivation for speaking
How many people are involved in the conspiracy?
What do they need to accomplish the plan?
What is the infrastructure of the project like?
out: they could suddenly become the heroes who opened the public’s eyes to the “truth.”
Even less obvious are the benefits that those who believe in the round Earth “conspiracy” reap! Adherents of the Flat Earth doctrine believe that our planet is a disk, that the Moon and the Sun revolve around it, that there is no force of gravity, and that instead of the arctic poles, a wall of ice rises along the edges of the disk. Why the powers that be would hide this from us remains a mystery.
How long can a conspiracy remain a mystery?
Why did a bunch of amateurs (as opposed to professionals) uncover the conspiracy?
Why hasn’t there been a single defector from the scientific community?
Of course, when discussing conspiracies, we would be careless not to mention E S and the PRISM program for its mass gathering of secret information, which was used by the US National Security Agency (NSA). At first glance, this is a simply canonical example of a conspiracy: a government organisation as the villain, plus mass surveillance, which is exactly what so many fear. But this example has several key di erences from the round Earth conspiracy. Firstly, the project was secret for only six years,
which is not very long. Secondly, the whistleblower was an employee of the NSA, who considered the program to be a crime against peace and humanity, as opposed to the “truth” being uncovered by strangers.
The most influential and powerful people on Earth, who have been able to dupe the rest of the population, must be extremely clever and make ingenious decisions.
Now, let’s recall the notorious chem trails : allegedly, the government sprays hazardous chemicals on the populations below from passenger planes fl ying overhead. But spraying poisons from a height of 9–11 km is an extremely ine ective and expensive solution. Surely cunning villains would come up with something more clever.
More dangerous and, unfortunately, more popular, is the anti-vaccination movement . Its adherents say that the production and sale of vaccines is an extremely lucrative business, and, therefore, doctors—in collusion with pharmaceutical companies—impose unnecessary and dangerous vaccines on us. Moreover, they claim that the data proving their e ectiveness is fabricated. But why would insidious doctors inject us with drugs that could worsen our health, hence deterring future potential patients from coming
Do the conspirators act rationally?
Is there a simpler way to get what they want?
R G derived a formula for calculating the lifespan of a conspiracy (how long it can remain secret) based on the number of people involved. To do so, he used data on already-uncovered conspiracies, including the PRISM project. So, according to his calculations, the Moon landing conspiracy could last only 3.7 years. Climate change, about 27 years if it involved only climatology scientists, and less than four if all global organisations were to reach a consensus on global warming.
to them for their services? It would be much easier just to administer vitamins or a saline solution. That way, there’s no harm done. Just a placebo.
Our brain is accustomed to looking for patterns and interrelations . This trait, called apophenia , helped our distant an cestors to survive in a world full of dangers. Those who believed that every rustle in the bushes was a fierce predator had greater chances of survival than their fellow tribespeople who were not inclined to panic and make blanket generalisations. Our brain can instantly assess a situation and determine whether a threat is present. But we can’t always form a complete picture of what is happening, which is why this property that is useful in principle sometimes grows into unfounded suspicion and even paranoia.
Our confirmation bias (the tendency to find confirmations of our own point of view) leads us to only pay attention to those arguments that support our argument and ignore everything that contradicts it. Because of this, conspiracy experts are immune to any influence. For example—all the arguments against a conspiracy are just part of the plot. Is the necessary supporting evidence lacking or impossible to find? It was simply destroyed by the all-powerful conspirators.
Theorists inherit a fundamental attribution error: they tend to attribute the actions of others to internal qualities and not to external factors. They ignore or downplay the role of chance, not believing that people can act rashly or under the pressure of circumstance, as opposed to malicious intent.
But, really, don’t waste your time searching for ill will in places where foolishness is visible to the naked eye.
Oxford physicist DHave you ever had a classmate who does things a bit differently than you do? Maybe they walk with a limp or they process information in their own way. You want to make friends with this person, but you feel awkward because you’re afraid you might accidentally offend them. In this article, we’ll introduce you to the world of people with limited mobility, neurodivergence, and genetic conditions. We’ll clue you in on what really offends them and how they prefer that people interact with them. Let’s go!
Our guide is Ekaterine Shabutskaya, a physical therapist and specialist in neurological challenges. Her daughter lives with cerebral palsy.
Try going outside with bright makeup on your face or wearing unusual clothing, such as a rainbow onesie or pink bunny pyjamas. How would people look at you?
This is how people with disabilities often feel when they’re out in public: they’re met with curiosity, fear, and sometimes disapproval. People either stare or turn away. Strangers are afraid to speak with them, smile at them, or ask for directions. This is one of the reasons why people with special needs sometimes prefer not to experience certain social interactions that most of us enjoy. Depending on where they live, another reason is that many people simply find it very di cult to get around the city. Even today, subways, building entrances and sidewalks in some areas are not wheelchair-accessible nor safe for people with walkers. Some buildings are constructed without ramps or elevators. Even if there is an elevator, sometimes it’s not big enough for a person with a wheelchair to enter and freely manoeuvre inside. Because of this, some people with limited mobility prefer to stay home and read, study or watch endless movies. Being a person with special needs means that you can be healthy but still stuck in an “eternal quarantine.”
All people are di erent. Some have red hair, while others have dark hair. Some are so tall that they have to stand in the bus hunched over, but others can’t even reach the handrails. Some walk, while others get around in wheelchairs. Some people can speak with their voice, while others — such as the late, famous astrophysicist S H — communicate only with the help of technology.
Without exception, all people have their own peculiarities. The main question is: do they prevent you from moving, communicating, making friends or doing your favourite things? If a person has features that do not allow them to go about their usual life, it may seem that they are ill. But drawing the line between health and illness is not so simple.
With viral, bacterial and fungal diseases, everything is straightforward. If you get exposed to harmful microbes, you fall ill and develop symptoms such as a cough or high temperature. Then you take medicine prescribed by your doctor, and eventually, the symptoms go away. You’re healthy again.
But there are much more complicated cases. For example, some people are Deaf from birth, but sometimes they can hear with the help of an implant or hearing aid. When their hearing aid works, some Deaf people can hear perfectly and their senses are no di erent from hearing people, while others are only able to pick up ambient noises in their environment. But if their device breaks down, everything goes silent again. So, are Deaf people disabled? The answer to this question actually depends on the society in which they live, not on the person themselves. If a Deaf person is given access to sign language, receives accessible, high-quality education, and is o ered the assistance of technology like the cochlear implant (if they so choose!), then
they have all the same opportunities and abilities as hearing people. Being Deaf is only a disability if society creates artificial barriers for non-hearing people.
This is also true for children with limited mobility. Ablebodied people walk, communicate, and go to work. If a person can walk in a wheelchair or with prosthetics, communicate and learn using a tablet or computer, or work from home or a specially-equipped o ce, then it seems they were never really disabled in the first place. After all, they can do all the same things that able-bodied people do, only a little di erently.
The accessibility and opportunities of people with special needs depend on you. You can talk and befriend them, ask them what kind of assistance they need — or whether they need it at all. As you get older, you can be the one to design buildings with large elevators and ramps instead of stairs, write software for tablets and eye trackers (which allow for typing text with eye movements), invent prosthetics that are indistinguishable from real hands and feet, and o -road wheelchairs (to go hiking through a forest or for a stroll in the park). If we can make these achievements, there will no longer be any “disabled” people among us, just people, our friends.
About 5 % of people in the world live with some kind of physical limitation. If there are a million people in your city, then about 50,000 of them will have “special needs.” The most common conditions are cerebral palsy, autism, and Down syndrome.
Cerebral palsy is a spectrum of disorders, but they share one important condition: in people with cerebral palsy, the area of the brain responsible for movement is a ected. This causes problems in how the brain controls the muscles. It is di cult for a person to maintain posture, move, and sometimes even speak (because the mouth contains muscles just like the arms and legs). Cerebral palsy has many causes. Examples include head injury (sometimes this happens right at the moment of birth), meningitis (inflammation of the meninges), or a stroke (when a brain vessel clogs and part of the brain stops receiving blood). Strokes occur not only in the elderly — they can occur in a newborn child or even in a foetus.
“Very often, a person with cerebral palsy can be trained to move better. This is done by physical therapists. Usually, people with cerebral palsy understand you perfectly, but sometimes, if their mouth is also paralysed, they can’t answer you. In this case, they will nod, smile, or frown. It’s great if they have a tablet or laptop handy: they can listen to your question, type their answer, and a special program will read it aloud.”
Down syndrome is a genetic disorder in which there is an extra copy of chromosome 21. Each cell usually has 46 chromosomes, but a person with Down syndrome has 47. The syndrome is caused by errors in the process of cell division, which “kicks o ’ the fusion of the egg and sperm. This process is not a ected by heredity or the environment: a child with Down syndrome can be born in any family.
“Extra” genetic material a ects human development. People with Down syndrome have weak muscles, so they might walk a little bit on tiptoe, and they sometimes speak slowly and not very clearly. Also, because their brains work slightly di erently, they learn at di erent rates.
“If you teach people with Down syndrome correctly, they successfully graduate not only from school but also from university, like the Spanish writer, actor and TED Talk lecturer P P . They also experience arthritis and heart disease more often than most people. Otherwise, they are no di erent from most people.”
Autism is more correctly called “autism spectrum disorder” (ASD), and the story is basically the same as with cerebral palsy: a wide variety of people with very di erent experiences are labelled autistic. All of them share a feature of the brain: as a rule, in ASD, a person begins to perceive signals either with exaggerated strength or too weakly. As with cerebral palsy, there are many causes of ASD. But while only motor control and skin sensitivity are altered in cerebral palsy, in ASD, the alterations often reach the brain areas responsible for visual, auditory, taste, or tactile sensitivity, as well as information processing, facial recognition, and emotions. These areas of the brain can be easily overloaded. Sometimes there are mixed variants of cerebral palsy and ASD, when a person has both at once.
We’re not exactly sure what causes ASD, but we do know what does not cause it. Scientists have analysed the medical histories of 1.2 million children with autism, and they have clearly proven that vaccinations do not play any role.
You should not limit your friend to their diagnosis. Many people really do not like it, because a person is always more than their physical features. It is impolite and unfair to view the presence of a wheelchair or speech di culties as being the essence of a person. Your friend has a name — call them by their name. There are no special forbidden words or taboos that will definitely destroy your friendship, but there are some very common insults that would o end anyone. Your friend in a wheelchair would also be o ended if you used these insults against them, for the same reasons any other person would be hurt. Don’t try to guess which words bother your friend or how they prefer to identify themselves. Get to know them better and they will tell you all about it.
“Have you ever been annoyed by an itchy scarf? Some people with ASD perceive any piece of clothing this way — and some may not feel anything even if they put their hands on a hot stove. Usually, the brain is able to filter out unnecessary information so that you’re not bogged down by the sound of a car that’s driving outside or all of the conversations going on in a noisy hall. The brains of some autistic people, however, continue to hear all sounds equally, and their brains cannot mute anything. As a result, the person gets tired and overwhelmed. Because of this, they can lose control of their actions.
If you have an autistic friend, be sure to ask what they don’t like and how you can help. For example, sometimes your friend might just need to bring along a pair of noise-cancelling headphones that drown out extra sound, and they will quickly feel better.”
More than anything, people with disabilities like it when people are interested in their opinions, behave sincerely, and ask directly whether they want or, conversely, do not want something. You can see for yourself: there are no “special features” to friendships with people with special needs. However, all people are di erent.
To make friends with any person, you need to get to know them thoroughly. This will be easier if you follow five simple rules.
Don’t make special people invisible. Many of us were forbidden in childhood from staring at people with Down syndrome, and even more so from asking if we could ride in someone’s wheelchair. Don’t be afraid to smile at people with special needs, approach them, and get acquainted. Take our word for it: being invisible is not fun at all.
Don’t be afraid to say what you need. Friendship is not an easy thing: tact, a sense of humour, ingenuity, and a willingness to help each other are required from all parties involved. So, it is perfectly normal to ask your friend to help with homework, give you a book to read, go to a cafe with you or help you choose a new T-shirt. If your friend asked for a favour, you would help, wouldn’t you?
Don’t impose by offering too much help, and don’t do ordinary tasks that your friend can easily take care of on their own. A person in a wheelchair is unlikely to be able to climb a tree in it, but they can easily look after your bag and jacket while you climb the tree. Children with special needs want to be friends, to be included in a common cause and to have their own share of responsibilities.
“My daughter is responsible for paper cutting in her class. She has a special button on her wheelchair that controls the electric scissors. It is important for her to participate in the class and help her friends.”
Ask questions. Ask what your friend thinks or feels, whether they need help and under what circumstances. If they don’t like the question, they won’t answer it. But the end result may be unexpected — maybe your friend has long dreamed of discussing a touchy topic that’s usually avoided by everyone.
Keep their limits in mind. Be thoughtful of your friend’s physical restrictions and be ready to help in an extreme situation. Usually, the most you’ll ever have to do is call an ambulance in an emergency and stay close until it arrives.
Hawking (2004) — A film about the astrophysicist’s youth. Hawking was played by B C in his first major role. There’s also a more recent movie about Hawking, The Theory of Everything
The Good Doctor — A series about a brilliant surgeon; like House , only this doctor has autism and savant syndrome.
Tamara — A short animation about a deaf girl who dreams of learning to dance. Watch to find out whether she succeeds.
Macropolis — A short animation about the fate of two toys that got discarded from a factory assembly line. The heroes dream of returning to their friends at the factory.
Rule №1: People who have special needs are people like everyone else. Do not ignore their di erences, but don’t fuss over them as if they were terminally ill.
Rule №2: Don’t be afraid to ask questions. It’s better to ask a stupid question once than to constantly trip over your words.
Rule №3: Don’t forget about yourself. Your friend wants to have their own areas of responsibility.
M P, The Gray House — Read this novel to remind yourself that children with special features are no di erent from us (when they do not turn into wolves or travel to other dimensions!).
A M, I Can Jump Puddles — The story of a boy who learned to walk again. If you like the book, you can read the other two parts of the trilogy, This is the Grass and In Mine Own Heart
M H, The Curious Incident of the Dog in the NightTime — The story of a boy with ASD who conducts his own investigation.
A N B, A Little Time — A book about the adventures of a brother, sister and a baby with Down syndrome.
the European Union, four smartphones are thrown out every second — more than 124 million devices end up in landfills every year. Modern smartphones are made up of 30 different elements from the periodic table , the reserves of some of which are limited or close to depletion.
The European Chemical Society has compiled a period ic table that shows the elements used in the production of
phones together with the status of their reserves. In addition to environmental effects, the authors of the table paid close attention to so-called “conflict minerals ”
For example, cobalt (Co) comes mainly from territories that are plagued by military conflict. Additionally, child labour is usual ly employed for its extraction. Currently, this metal is not classified as a conflict mineral, but its status is continuously reviewed.